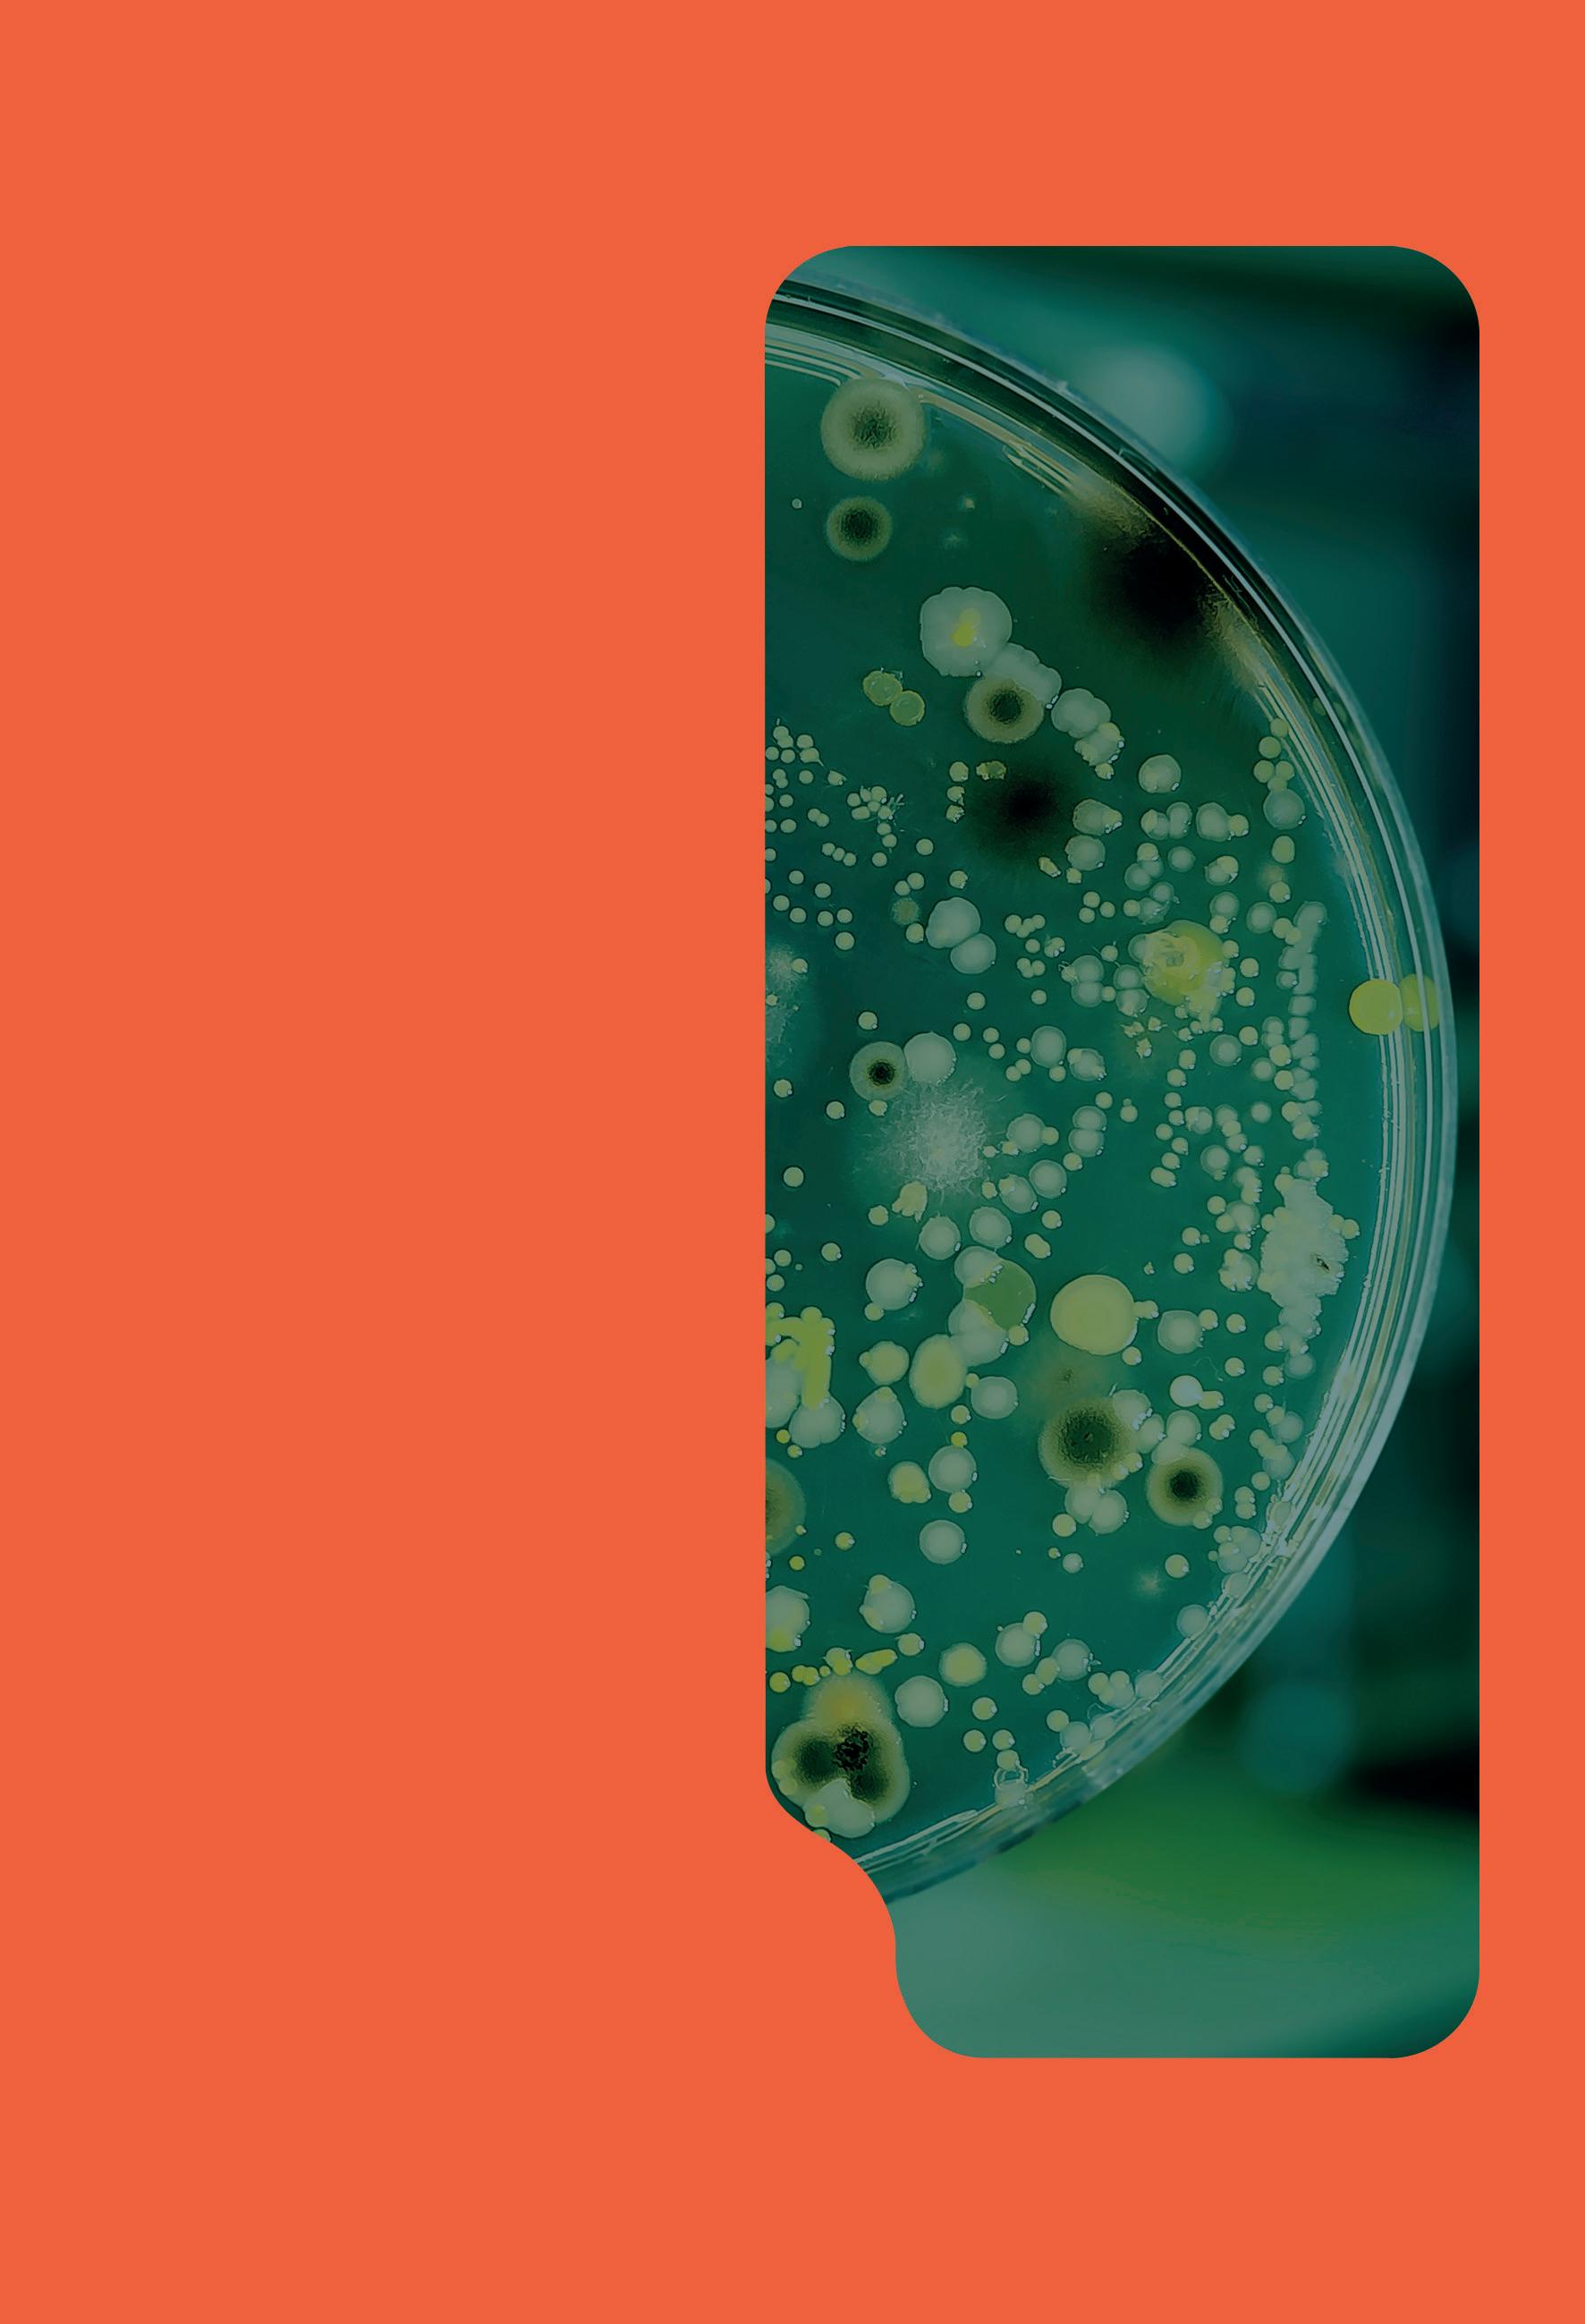

Revista de Controle Biológico


A importância e os desafios do manejo integrado de pragas (MIP): o exemplo da cultura da soja

TECNOBIO: O MAIOR
EVENTO DE CONTROLE

BIOLÓGICO DO BRASIL
COMEMORA UMA DÉCADA DE EXISTÊNCIA
A microbiologia na nutrição de canaviais
Manejo biológico acelera desenvolvimento e reduz perdas no canavial
ANO 1 | n° 03 | Agosto de 2022
Distribuição gratuita
LANÇAMENTO



CONTROLE SUSTENTÁVEL PARA UM DESEMPENHO SEM COMPARAÇÃO.



Inlayon ECO é ciência, é tecnologia que combina sustentabilidade e proteção para o seu canavial. É um nematicida microbiológico desenvolvido com cepa especializada no controle de nematoides. É uma solução compatível com as práticas agrícolas e de manejo, com desempenho e excelência comprovados.





LANÇAMENTO








Omsugo ECO é o primeiro inoculante solubilizador de fósforo para a cultura de cana-de-açúcar. Ele é composto por duas cepas de bactérias distintas, que foram exclusivamente selecionadas e desenvolvidas pelos pesquisadores da Embrapa. Trata-se de um produto biológico capaz de solubilizar o fósforo retido no solo e na matéria orgânica, além de maximizar a eficiência nutricional das plantas por meio de um melhor aproveitamento da adubação fosfatada, contribuindo com a produtividade e a longevidade do canavial e otimizando os investimentos passados e futuros na lavoura.





Abrace um futuro equilibrado. #CanaÉCorteva 0800 772 2492 | saiba mais: corteva.com.br ™ ® Marcas registradas da Corteva Agriscience e de suas companhias afiliadas. ©2022 Corteva. Omsugo ECO é um inoculante solubilizador de fósforo registrado no MAPA sob no RS 003401-0.000035. PIONEIRISMO
E SUSTENTABILIDADE JUNTOS. SÓ PODIA SER CORTEVA.
Editorial
O Tecnobio CANA é o evento mais importante do controle biológico de pragas no Brasil e comemorará uma década em 2022. Essa edição da Revista de Controle Biológico é dedicada a esse evento. Os renomados palestrantes do Tecnobio deixaram seu depoimento sobre suas palestras e uma breve história do evento será compartilhada com todos vocês.


Mas essa edição não trata só do evento. O Manejo Integrado de Pragas da soja está crescendo e temos um artigo sobre esse tema. O controle de qualidade de biodefensivos é uma preocupação atual e será discutido aqui. E os lindos textos sobre polinizadores e a polinização de espécies vegetais importantes será tratado mais uma vez na seção PÓLEN.
Hoje, a busca pela informação verdadeira e confiável é um dos grandes entraves para o avanço da agricultura. Muitas tecnologias falsas e enganosas levam o agricultor a perder tempo precioso e dinheiro. É preciso se informar com fontes confiáveis. A nossa revista que colaborar com o agricultor com informações sérias a muito atuais, em uma linguagem simples e direta.
Que essa edição seja útil a todos!
Alexandre de Sene Pinto Editor
Gebio Revista de Controle Biológico Agosto de 2022
ANO 1 . NÚMERO 3
EDITOR
Alexandre de Sene Pinto alexandre@occasio.com.br
ADMINISTRAÇÃO
Fabio Bueno fabio@occasio.com.br
VENDAS DE PUBLICIDADE
Ligia Rizzo gebio@occasio.com.br
PROJETO E
ARTE-FINALIZAÇÃO
Senha Assessoria em Comuninação sac@senhaonline.com.br
Diagramação Rodrigo Ferreira Iwahashi
FOTO DA CAPA: Fabio Bueno
GRÁFICA
Grupo Saint Edwiges de Artes Gráficas
OCCASIO editora e análises técnicas Ltda-ME
Rua do Trabalho, 396 Vila Independência, Piracicaba, SP 13.418-220
Distribuição Gratuita
Todo o conteúdo dos artigos é de responsabilidade dos autores que assinam.
Tiragem dessa edição: 2.000 exemplares
Dúvidas, opiniões ou sugestões, escrever para contato@occasio.com.br
Quer anunciar?
gebio@occasio.com.br
Sumário
6
AGENTES
Controle de qualidade de inimigos naturais: impacto de infecções por patógeno em produções de Diatraea saccharalis e Cotesia flavipes


9 15
MANEJO

A importância e os desafios do manejo integrado de pragas (MIP): o exemplo da cultura da soja
PESQUISA
O controle biológico em plantas BT






27
TECNOBIO
O estado da arte do controle biológico no Brasil
30
TECNOBIO
A microbiologia na nutrição de canaviais

33
TECNOBIO
Controle de cupins e formigas na cana-deaçúcar
17 22 25
PÓLEN
Jardim amigável às abelhas: margaridão (Tithonia diversifolia)
TECNOBIO
TECNOBIO: o maior evento de controle biológico do Brasil comemora uma década de existência

TECNOBIO
Manejo biológico em canaviais: o que tem de novo?
38 40 44
TECNOBIO
Por que usar Trichoderma?



TECNOBIO
Manejo biológico acelera desenvolvimento e reduz perdas no canavial
TECNOBIO
Uma revolução no controle das pragas dos canaviais!
Agentes
CONTROLE DE QUALIDADE DE INIMIGOS
NATURAIS: IMPACTO DE INFECÇÕES POR
PATÓGENO EM PRODUÇÕES DE DIATRAEA
SACCHARALIS E COTESIA FLAVIPES
Acana-de-açúcar ocupa posição de destaque no agronegócio brasileiro, fato este que, confere ao país a posição de líder mundial na produção desta cultura. Entretanto, são muitos os entraves enfrentados durante o processo de produção, dentre eles, se encontram as pragas que causam perdas econômicas no campo, tal como, a broca-da-cana, Diatraea saccharalis, que apresenta
grande potencial destrutivo em lavouras de cana-de-açúcar.
Os danos ocasionados pela presença de D. saccharalis em cultivos de cana-de-açúcar são em decorrência da alimentação das lagartas deste inseto, as quais abrem galerias no colmo e geram perda de biomassa. Além disso, são evidenciados danos indiretos à alimentação das lagartas da
broca, os quais são ocasionados por fungos, como espécies de Fusarium e Colletotrichum, que desenvolvem podridões e prejudicam o processo de fermentação, afetando com isso a produção de açúcar e álcool.
Diante da importância deste inseto como praga em cultivos de cana-de-açúcar, é importante a tomada de medidas de controle baseadas no

6
Por Dra. Nadja Nara Pereira da Silva
Dra. Regiane Cristina de Oliveira Faculdade de Ciências Agronômicas/UNESP, Botucatu, São Paulo
Shutterstock
Manejo Integrado de Pragas (MIP). Hoje a principal tática de controle empregada para o controle de D. saccharalis em canaviais no Brasil é a utilização de produtos biológicos. O manejo da broca-da-cana é considerado um dos maiores programas de controle biológico em nível mundial e o mais importante em funcionamento no país. Os principais inimigos naturais empregados em liberações inundativas são pertencentes ao grupo dos parasitoides, com destaque para o uso do parasitoide larval, Cotesia flavipes (Cameron) (Hymenoptera: Braconidae).
Cotesia flavipes é uma vespa que deposita os seus ovos no interior das lagartas da broca-da-cana, e ao emergirem do interior da lagarta, as larvas do parasitoide matam esta praga. Essa vespa foi introduzida em 1970 no Brasil visando o manejo de D. saccharalis e atualmente, cerca de 3,5 milhões de hectares de cana-de-açúcar são tratados com este parasitoide.

Apesar da eficiência e ampla utili-
Agentes
zação de C. flavipes como agente de controle de D. saccharalis, existe uma preocupação com a qualidade dos parasitoides produzidos massalmente e, isto se deve principalmente a diminuição na capacidade de voo e dispersão deste parasitoide em cam-
po nos últimos anos no Brasil. Dentre os fatores que estão relacionados com as alterações na eficiência de C. flavipes é a infecção pelo patógeno Nosema sp., a qual contrai este microrganismos ao parasitar as lagartas de D. saccharalis infectadas.

7
Esporos de Nosema sp. isolados do conteúdo intestinal de D. saccharalis (Foto: PAES et al., 20191).
1 PAES, J.P.P et al. Infection by the microsporidium of Clado Nosema/Vairimorpha in pupal parasitoids. Anais da Academia Brasileira de Ciências, v.91, 2019
Agentes
Nosema sp. foi considerada por muito tempo um protozoário, entretanto, atualmente pertence a um táxon do reino Fungi, do filo Microsporidia. São parasitas intracelulares de vertebrados e invertebrados, incluindo os insetos. Infecções por este patógeno em criações de D. saccharalis são comuns em produções massais, desencadeando diversos efeitos deletérios neste inseto, tais como, desenvolvimento larval incompleto, coloração branco-leitosa, dilatação (formação de nódulos) na parte posterior da lagarta e pontos de necrose em diversas regiões do corpo. Além disso, é observada uma diminuição na alimentação, tendo como consequência direta a redução no tamanho e peso das lagartas.
A transmissão do patógeno ocorre em todos os indivíduos de C. flavipes que se desenvolvem na lagarta da broca-da-cana infectada, independentemente do nível de infecção deste inseto. A infecção por Nosema sp. resulta em alterações negativas na emergência, fecundidade, longe-
vidade, tamanho e capacidade de voo de C. flavipes quando se desenvolvem em lagartas de D. saccharalis infectadas por Nosema sp., bem como, afeta a capacidade de busca da vespa pelo hospedeiro, a broca-da-cana, resultando em baixa eficiência de controle em campo.
Houve um aumento na frequência de infecções da broca-da-cana e do parasitoide, C. flavipes desde os primeiros registros de infecção, o que se deve principalmente pela capacidade de transmissão de Nosema sp. nestes insetos, a qual ocorre tanto de forma vertical (fêmea infectada transmite para a progênie) como horizontal (liberação de esporos pelas fezes e seda das lagartas infectadas e por indivíduos mortos), mantendo-se no hospedeiro durante todo o desenvolvimento. Além do que, as técnicas de criação em massa empregadas para a produção da broca-da-cana, onde é produzida uma elevada densidade de lagartas por potes de criação, favorece a transmissão deste patógeno entre os insetos.

Medidas que visam a redução e/ou descontaminação da infecção de Nosema sp. em criações da broca-da-cana são baseadas na eliminação de indivíduos com sintomas aparentes da infecção, seleção e reprodução de insetos sadios, bem como, estudos recentes estão voltados para a utilização de produtos com atividade antimicrobiana durante a alimentação das lagartas de D. saccharalis a fim de fornecer subsídios para o manejo da doença na produção massal da broca-da-cana e do parasitoide, C. flavipes
Diante da importância de programas de controle biológico com a utilização de C. flavipes para o controle de D. saccharalis, é de extrema importância o aprimoramento do controle de qualidade durante o processo de produção destes insetos, a fim de se obter parasitoides sadios e capazes de controlar a praga alvo em campo, garantindo com isso, o sucesso deste programa em canaviais brasileiros.
8
Shutterstock
A IMPORTÂNCIA E OS DESAFIOS DO MANEJO INTEGRADO DE PRAGAS (MIP):
O EXEMPLO DA CULTURA DA SOJA
Ocrescente aumento da população mundial e consequente demanda por alimentos, faz com que seja necessário aumentar a capacidade produtiva no campo. No entanto, a preocupação com o meio ambiente cresce junto com a necessidade de produção, sendo assim a

busca por ferramentas que proporcionam sustentabilidade e eficiência se faz necessária constantemente. Neste contexto, a principal tecnologia disponível é o Manejo Integrado de Pragas (MIP), que apesar de ser uma realidade antiga (1970 – Brasil), atualmente, ainda não é adotada na

intensidade que deveria, mas se encontra em plena ascensão quanto sua adoção no campo na atualidade.
O MIP consiste na utilização de diversas ferramentas de manejo com o intuito de realizar um controle mais efetivo e sustentável de insetos praga. A base do MIP considera que nem

9 Manejo
Por MSc. Rodrigo M. Antunes Maciel Universidade Federal do Paraná (UFPR), Curitiba, PR
Por Dr. Adeney de Freitas Bueno Embrapa Soja, Londrina, PR
Shutterstock
Manejo
todos os insetos são pragas e que as plantas toleram certos níveis de ataque de insetos sem perdas econômicas de produtividade. Portanto, o manejo é baseado em níveis de tomada de decisão (níveis de ação) a partir do monitoramento de pragas em campo. Na soja, a principal forma de monitoramento é o pano de batida, uma ferramenta que proporciona assertividade na tomada de decisão, todavia é uma ferramenta que demanda muita mão-de-obra. Mão-de-obra de qualidade é cara e sua manutenção pode ser um problema em qualquer atividade comercial, principalmente, relacionado ao campo, dificultando e podendo até inviabilizar um monitoramento de melhor qualidade. Portanto, podemos considerar a necessidade de mecanização ou pelo menos de redução da mão de obra na amostragem o primeiro grande

desafio para intensificar o uso do MIP-Soja. Precisamos desenvolver estratégias de monitoramento de pragas mais rápidas e baratas, mas com a mesma ou até maior eficiência que o pano de batida visando escalonar a adoção do MIP-Soja em campo. Muitas alternativas vêm sendo estudadas e até utilizadas em pequena escala, mas ainda com limitações que não permitem dispersar a adoção do pano-de-batida. Entre essas novas ferramentas está o monitoramento através de satélites, uso de armadilhas entre outras formas, que com o avanço da pesquisa poderão proporcionar maior adoção do MIP em futuro próximo.
A partir do monitoramento adequado, diversas ferramentas de controle devem fazer parte do MIP, tais como, o uso racional do controle químico, o controle biológico, cultural e ge-
nético, entre outras. Estratégias de genética avançada estão atualmente na fronteira do conhecimento, destacando-se entre elas o uso de insetos geneticamente modificados como a “Spodoptera Do Bem”, por exemplo, além do RNAi entre outras novidades que já estão ou estarão disponíveis aos sojicultores em um curto espaço de tempo. O ponto crucial na escolha das ferramentas para o manejo de pragas é considerar além de sua eficiência também o impacto ambiental, e, principalmente, a compreensão que nenhuma ferramenta, por mais sustentável ou eficiente que seja, não deve ser utilizada de maneira individual. Grandes exemplos disso são o uso da soja Bt e dos inseticidas químicos. Apesar de sua boa eficiência inicial, devido ao uso errôneo e muitas vezes errada dessas tecnologias como a não adoção da área
10
Monitoramento de pragas na cultura da soja com o pano de batida.
de refúgio e não rotação de modos de ação, para plantas Bt e inseticidas, respectivamente, estão entre os erros que se destacam para a seleção de populações de pragas resistentes à essas tecnologias.

Nesse cenário de perda de efetividade das principais ferramentas de manejo de pragas associado a uma crescente demanda do mercado consumidor por utilização de tecnologias mais limpas, menor uso de defensivos sintéticos, a principal alternativa que vem se destacando é o controle biológico. O controle biológico pode ser o natural onde estratégias de controle biológico conservativo devem ser adotadas para preservação e aumento da população desses insetos benéficos naturalmente existentes na natureza, permitindo que o ambiente proporcione maior equilíbrio entre popula-
ções de pragas e inimigos naturais. Alternativamente o controle biológico aplicado ou aumentativo pode ser também utilizado o que consiste na aplicação ou liberação de inimigos naturais como microrganismos (bactérias, fungos, vírus e nematoides) ou mesmo macroorganismos (predadores e parasitoides) para o controle de pragas.
Um exemplo muito claro do sucesso do MIP com ou sem a utilização de controle biológico ocorre na cultura da soja no estado do Paraná. Em uma parceria entre Embrapa Soja e IDR – Paraná (antiga Emater Paraná), técnicos do IDR realizam monitoramento de lavouras de soja, com e sem adoção de MIP, desde 2013 até a atualidade, e os resultados obtidos demonstram que a adoção do MIP, proporciona manter a produtividade, gastando menos inseticidas, o que resulta, portanto, em maior lucrati-
vidade. Outro caso que trouxe bons resultados, foi a utilização de Trichogramma pretiosum, um parasitoide de ovos de lepidópteros, gerando controle satisfatório e diminuindo a pressão de seleção de populações resistentes. Atualmente, o parasitoide de ovos de percevejos Telenomus podisi vem sendo também utilizado, com maior intensidade a cada ano. Essa combinação de inimigos naturais, juntamente com monitoramento e utilização racional de outras ferramentas disponíveis dentro do MIP, preferencialmente aquelas menos impactantes, proporciona maior sustentabilidade e aceitação pelo mercado consumidor mundial, que demanda por alimentos “limpos” e sustentáveis, produzidos com uso zero ou reduzido de defensivos sintéticos. Estudos recentes mostram que áreas que adotaram controle biológico aplicado tiveram menor
11
Tipos de armadilhas: (A) tipo Bola em estudo em parceria Embrapa e Agribela e (B) R Biando usada em sojicultura orgânica para controle de percevejos.
Manejo
Manejo
emissão de CO2 equivalente comparado com áreas com a mesma cultura sem adoção de controle biológico aplicado. Isso é uma indicação clara que a maior adoção de MIP e controle biológico na agricultura auxilia

na mitigação do aquecimento global, uma séria ameaça atual à nossa sociedade. Adoção de MIP associando estratégias de manejo de pragas como o controle biológico, plantas Bt com a devida adoção de área de re-
fúgio, RNAi e outras ferramentas ou bioinsumos sustentáveis é uma necessidade e demanda sem volta para agricultura brasileira e mundial e o sojicultor que não se adequar a essa realidade estará fora do mercado em
12
Ciclo de desenvolvimento de Trichogramma pretiosum
um curto espaço de tempo.
O mercado tem respondido a essa demanda com ofertas crescentes de produtos a cada ano. Atualmente o número de produtos biológicos registrados no Brasil se aproxima de 500 e cresce rapidamente. O MIP, no cenário contemporâneo não se mos-

tra mais como uma novidade que deve ser aceita, mas sim como uma realidade que deve ser adotada em todos os cultivos, pois além de ser mais sustentável, traz maior rentabilidade ao campo, reduzindo custos a longo prazo. Além dos benefícios diretos para a produção no campo,
os efeitos do MIP no meio ambiente não quantificáveis, como a saúde do homem e seu meio ambiente, são incalculáveis, pois tratam-se dos bens mais preciosos que proporcionam qualidade de vida para a população.
Adote MIP: é bom para sua saúde física e econômica.
13
Manejo
Ciclo de desenvolvimento de Telenomus podisi
Manejo
Programa de adoção do MIP-soja no Estado do Paraná com a adoção de inseticidas seletivos.
Análise comparativa entre resultados médios de diferentes estratégias de manejo de pragas utilizadas na soja. Paraná, safra 2013/2014.
médio de aplicações
1MIP+CB: Manejo integrado de pragas com controle biológico (liberação de T. pretiosum) (19 lavouras); MIP: Manejo integrado de pragas (27 lavouras); sem MIP: Manejo convencional de produtores que não adotam MIP (333 produtores).
2Preços médios: Saca de soja = R$ 60,00; Serviços de pulverização = R$ 24,79/ha; Cartela T. pretiosum = R$ 15,00; Serviço mão de obra de liberação T. pretiosum = R$ 5,83/ha.
3Valor do inseticida de R$ 54,10 e custo médio da cartela de T. pretiosum de R$ 34,05/ha.
4Serviço de pulverização de R$ 50,82 e mão de obra para liberação de T. pretiosum de R$ 5,83/ha.
14
Variáveis/Comparação Safra 2013/14 2014/15 2015/16 2016/17 2017/18 Número de aplicações de inseticidas Com adoção de MIP 2,3 (46 áreas) 2,1 (106 áreas) 2,1 (123 áreas) 2,0 (141 áreas) 1,5 (196 áreas) Sem adoção de MIP 5,0 (333 áreas) 4,7 (330 áreas) 3,8 (314 áreas) 3,7 (390 áreas) 3,4 (615 áreas) Dias até a primeira aplicação de inseticida Com adoção de MIP 60 dias 66 dias 66,8 dias 70,8 dias 78,7 dias Sem adoção de MIP 33 dias 34 dias 36 dias 40,5 dias 43,6 dias Custo do controle de pragas (sacas/ha) Com adoção de MIP 2,41 2,00 2,00 2,30 1,41 Sem adoção de MIP 5,03 5,00 4,00 4,10 3,27 Produtividade (sacas/ha) Com adoção de MIP 49,23 60,20 57,10 64,50 61,7 Sem adoção de MIP 48,67 58,60 54,70 64,20 60,4 Manejo1
Dias
Custo R$/ha2 Custo2 (sc/ha) Produtividade (kg/ha) Insumos3 Serviço4 Total MIP+CB 2,05 61 88,2 56,7 144,8 2,4 2903,4 MIP 2,60 54 80,1 64,5 144,6 2,4 3004,2 sem MIP 4,99 – 178,6 123,5 302,1 5,0 2920,2
Número
até 1ª aplicação
O CONTROLE BIOLÓGICO EM PLANTAS BT
 Por Dra. Tamara Akemi Takahashi
Por Dra. Tamara Akemi Takahashi
a adoção de boas práticas agrícolas; como a presença da área de refúgio, ou seja, o plantio de uma cultivar que não expresse resistência ao ataque de insetos em uma determinada área da lavoura.
Além das espécies de insetos que podem apresentar resistência às proteínas presentes nas plantas Bt, outro problema comumente constatado é o aumento expressivo de espécies não suscetíveis e/ou não-alvo da tecnologia, que passam a ocupar o nicho deixado pelos insetos que são controlados pelo Bt, podendo ocasionar danos econômicos consideráveis à cultura.
As plantas geneticamente modificadas (GM), que expressam proteínas com ação inseticida derivadas da bactéria Bacillus thuringiensis (Bt), fazem parte das mais modernas formas de controle de insetos-praga disponíveis no mercado. Essa tecnologia proporciona um manejo eficaz dos insetos-alvo, uma vez que a expressão da toxina ocorre em todos os tecidos da planta. Além da possibilidade de aumento na produtividade, obtido através do controle eficiente dos insetos-alvo, as plantas Bt quando utilizadas corretamente, podem
facilitar o manejo da lavoura por meio da diminuição da necessidade de aplicação de inseticidas químicos para as pragas que são alvo da tecnologia. Assim, também é possível observar um impacto positivo para a saúde humana e ao meio ambiente.
Apesar das vantagens do cultivo de transgênicos Bt, um dos maiores desafios para o uso sustentável dessa tecnologia está relacionado ao retardo da evolução da resistência de insetos às proteínas do Bt, cujo progresso pode ser atenuado com
Uma vez que a utilização de uma única estratégia de manejo de pragas tem efeito apenas a curto prazo, é necessário a associação de outros métodos de controle, assim como já preconizado pelo Manejo Integrado de Pragas (MIP). Sendo assim, se uma das vantagens do uso de plantas Bt é a consequente redução na utilização de inseticidas químicos, então é incoerente a utilização do método químico associado às plantas Bt como primeira opção de manejo.
Dentro do MIP, há outros métodos e estratégias de controle que devem ser exploradas. Dentre elas, o controle biológico se destaca pela eficácia e sustentabilidade no seu uso. Porém, o controle biológico é compatível com plantas Bt? Inúmeras questões
15 Pesquisa
Pós-doc no São Paulo Advanced Research Center for Biological Control – SPARCBIO, Piracicaba, SP
Shutterstock
Pesquisa
sobre esse tema foram abordadas ao longo dos últimos 20 anos. A principal polêmica que envolve esse assunto é que, com a mudança nas espécies de pragas que ocorrem no agroecossistema em lavouras Bt, consequentemente há uma mudança na interação das pragas (hospedeiros ou presas) com seus inimigos naturais (predadores e parasitoides).
Para que as populações de inimigos naturais se estabeleçam e permaneçam na lavoura é necessário que as condições abióticas e bióticas sejam favoráveis. As plantas Bt alteram o perfil das lagartas presentes na lavoura, influenciando diretamente na disponibilidade de hospedeiros ou presas. Sendo assim, esta alteração pode afetar os inimigos naturais?
Estudos que avaliaram a comunidade de inimigos naturais presentes em áreas de cultivos Bt em relação a lavouras convencionais com ou sem aplicação de inseticidas químicos concluíram que existe uma redução em algumas espécies de agentes de controle biológico nas áreas de cultivo Bt quando comparadas com áreas não-Bt que não receberam pulverizações de inseticidas químicos. No entanto, essa redução é pequena ou não relevante pois, quando comparado a abundância de espécies de uma área Bt em relação a uma área não-Bt com aplicação de inseticida de amplo espectro, a redução na biodiversidade é altamente relevante.
Ou seja, a aplicação de inseticidas de amplo espectro em lavouras com sementes convencionais causa maior impacto na fauna benéfica de um agroecossistema se comparado ao efeito do cultivo de plantas Bt.
Em uma tese defendida na Universidade Federal do Paraná em 2021, um estudo de campo foi realizado durante três safras da soja, avaliando o impacto de uma cultivar Bt em comparação a uma cultivar não-Bt na comunidade de parasitoides presentes nas áreas. Como resultado do
trabalho, a maior abundância de parasitoides de ovos foram constatadas na área Bt durante as três safras avaliadas.
Proveniente dessa tese, três novas espécies de parasitoides de ovos do gênero Telenomus e uma nova espécie de parasitoide larval do gênero Aleiodes foram coletados em lavoura de soja Bt atacando importantes pragas da cultura. Na área não-Bt uma nova espécie de vespinha do gênero Trichogramma foi encontrada e descrita como Trichogramma foersteri, nome dado em homenagem ao Dr. Luís Amilton Foerster, professor aposentado da UFPR.

A descoberta das novas espécies de inimigos naturais foi atribuída ao fato de as áreas estudadas adotarem as práticas de MIP, o que possibilitou um ambiente favorável à conservação dos inimigos naturais. Pesquisas estão sendo conduzidas com os parasitoides T. foersteri e Aleiodes sp. n. na Escola Superior de Agricultura “Luiz de Queiroz” (USP/ESALQ), a fim de determinar o potencial de utilização dessas espécies para o controle biológico.
Mesmo que plantas Bt alterem as espécies de pragas encontradas em campo, a tecnologia não impede que o controle biológico ocorra naturalmente, e que novas espécies de inimigos naturais sejam encontradas para que possam ser utilizados em grande escala. No Brasil, atualmente mais de 60% das cultivares na cultura do algodoeiro, milho e soja apresentam resistência ao ataque de insetos-alvo. Recentemente a primeira cultivar de cana-de-açúcar Bt foi liberada para o plantio comercial. O atual cenário demonstra o enorme potencial em que o controle biológico pode ser inserido e explorado, tornando a produção agrícola mais sustentável e gerando menor impacto ambiental. ser inserido e explorado, tornando a produção agrícola mais sustentável e gerando menor impacto ambiental.
16
JARDIM AMIGÁVEL ÀS ABELHAS: MARGARIDÃO (TITHONIA DIVERSIFOLIA)
 Por Profa. Dra. Darclet Teresinha Malerbo-Souza Setor de Apicultura e Meliponicultura, Departamento de Zootecnia, Universidade Federal Rural de Pernambuco, Recife, PE
Por Profa. Dra. Darclet Teresinha Malerbo-Souza Setor de Apicultura e Meliponicultura, Departamento de Zootecnia, Universidade Federal Rural de Pernambuco, Recife, PE
Um dos mais importantes serviços ecossistêmicos é a polinização. Por esse processo, o pólen, contendo o gameta masculino, é transferido para os órgãos reprodutores femininos de uma planta, fertilizando o óvulo e formando um embrião. Os estudiosos concordam que o grupo de polinizadores que mais se destaca é constituído pelos insetos (polinização entomófila) e, dentro deste grupo, as abelhas são os polinizadores mais importantes, destacando a abelha doméstica Apis mellifera
Silveira et al. (2002)1 concluíram que a diversidade no grupo das abelhas e as adaptações morfológicas tanto nas estruturas de coleta quanto nas de transporte, fisiológicas, e comportamentais otimizam a localização e a exploração dos recursos florais. Acredita-se que abelhas e angiospermas coevoluíram mutuamente ao longo do tempo evolutivo, beneficiando os dois grupos envolvidos. Temos mais de vinte mil espécies de abelhas catalogadas e a cada período novas espécies vêm sendo descobertas2
Conhecer o período de floração, durante o ano, possibilita introduzir espécies vegetais que floresçam e forneçam néctar e pólen às abelhas, nas épocas de escassez de recursos flo-
rais. O período de floração, a produção de néctar e pólen, odor e outras características são variáveis de atração de determinados grupos de polinizadores. O néctar é, boa parte das vezes, a única fonte energética para atividade metabólica de seus polinizadores. A planta gasta parte da sua energia na produção de néctar como atrativo para os visitantes florais.
Pensando nisso, uma das espécies vegetais muito visitada pelas abelhas é o margaridão (Tithonia diversifolia), popularmente conhecido como girassol mexicano, mão-de-Deus ou flor do mel. É um arbusto perene
que faz parte da família Asteraceae, podendo alcançar mais de três metros de altura, tem origem na América Central, muito utilizado como cerca viva devido à beleza de suas flores. No Brasil, muitas vezes, ele é considerado uma planta invasora. O margaridão tem sido utilizado em algumas áreas agrícolas como adubo verde para melhoria dos solos, devido aos seus atributos como a rápida decomposição da fitomassa, o rápido crescimento, e produção de folhas abundante.
Moura (2011)3 constatou que o margaridão apresenta uma inflorescên-
1 SILVEIRA F. A., MELO G.A.R., ALMEIDA, E.A.B. Abelhas brasileiras: sistemática e identificação. Belo Horizonte, Ministério do Meio Ambiente, 2002
2 DEL-CLARO K, TOREZAM-SILINGARD, H.M. Ecologia das Interações Plantas-Animais: uma abordagem ecológico evolutiva. Rio de Janeiro, Technical Books Editora, 2012.
3 MOURA, J.T, et al. Aspectos da biologia floral e visitantes florais de Tithonia diversifolia (Asteraceae) no município de Rio Largo- Estado de Alagoas. 2012. Disponível em: <https://www.apacame.org.br/mensagemdoce/116/polinizacao12.htm>.
4 GAZZONI, D.L. Plantas que os polinizadores gostam. Brasília, DF: Embrapa, 2021 1016p
17 Pólen
Florada do margaridão (Thitonia diversifolia).
cia com flores hermafroditas, pentâmeras e simétricas. Apresentam, em média, 160 flores perfeitas com cálice composto por duas sépalas. De acordo com Gazzoni (2021) , as flores periféricas são liguladas, vistosas, de coloração amarelo-intenso. As flores do disco central são férteis, com duas sépalas, agudas, unidas até pouco mais da metade. A corola é formada por cinco pétalas unidas em quase toda a extensão, com os lobos agudos, sendo mais densamente pilosas na base. Possui cinco estames, com anteras castanhas, unidas em tubo. O ovário ínfero, unilocular, uniovulado, encimado por um estilete longo com dois estigmas divergentes amarelos. O fruto é um aquênio de até dois centímetros de comprimento.
O margaridão é muito importante para a preservação da biodiversidade, por ser melissotrófico (produtor de pólen e néctar) e ornitotrófico (produtor de sementes nutritivas para alimentação, principalmente
de aves granívoras) e, também por florescer nos meses do outono e do inverno, momento de escassez de floradas nativas (PEDROSA, 2016)5
Um experimento foi conduzido na Universidade Federal Rural de Pernambuco (GABRIEL, 2018)6, localizada em Recife, Pernambuco para avaliar a frequência das visitações, o comportamento forrageiro e o tipo (néctar e/ou pólen) de coleta dos insetos nas flores do margaridão, no decorrer do dia. Esses dados foram obtidos por contagem nos primeiros 10 minutos de cada horário, entre as 6h00 e as 17h00, com três repetições, durante três dias distintos, em agosto de 2018. A contagem foi realizada percorrendo o entorno da planta e anotando-se os insetos presentes nas flores, bem como, o que estavam coletando (néctar ou pólen). O comportamento de forrageamento de cada espécie de inseto foi avaliado através de observações visuais, no decorrer do dia, no período experimental.
Porcentagem de insetos
Dípteros
Halic�deos Lepidópteros
Trigona spinipes
Xylocopa frontalis
Megachile rotundata
Melipona scutellaris
Apis mellifera
Apis mellifera



Melipona scutellaris
Megachile rotundata
Xylocopa frontalis
Trigona spinipes
Halic�deos
Lepidópteros
Dípteros
Foram observados apenas insetos coletando néctar e pólen, nas flores do margaridão. Os insetos observados foram abelhas africanizadas Apis mellifera (58,85%), dípteros (8,50%), lepidópteros (8,50%), abelhas Megachile rotundata (7,15%), abelhas sem ferrão Melipona scutellaris (6,8%), abelhas solitárias Xylocopa frontalis (5,1%), abelhas sem ferrão Trigona

Porcentagem de visitantes florais no margaridão (Thitonia diversifolia), em Recife, Pernambuco, em 2018.
Abelha africanizada Apis mellifera coletando néctar, nas flores do margaridão (Thitonia diversifolia).
Abelha africanizada Apis mellifera coletando néctar e coberta de pólen, nas flores do margaridão (Thitonia diversifolia).
Abelha africanizada Apis mellifera com corpo repleto de pólen, nas flores do margaridão (Thitonia diversifolia).
Abelha uruçu nordestina Melipona scutellaris coletando néctar, nas flores do margaridão (Thitonia diversifolia).
5 PEDROSA, M. G. Importância ambiental dos margaridões amarelos da estação Jaraguá. 2016. Disponível em: <https://jaraguasp.blogspot. com/2016/07/importancia-ambiental-margaridoes-amarelos-estacao-jaragua.html> Acesso em 07 de janeiro de 2019.
6 GABRIEL, R.I.O.A. Importância do margaridão (Thitonia diversifolia) como fonte de alimento para abelhas africanizadas e nativas. Monografia, UFRPE, 2018 25p.
18
Pólen
spinipes (3,74%) e uma espécie de abelha da família Halictidae (1,36%). Observou-se que houve predominância das abelhas africanizadas nas flores em relação aos outros insetos.

As abelhas africanizadas preferiram coletar néctar (53,07%) comparado ao pólen (46,93%). Para coleta de néctar, essas abelhas foram mais frequentes, nas flores do margaridão, entre 12h00 e 14h00, com pico de frequência às 13h00. Para coleta de pólen, essas abelhas visitaram as flores das 8h00 às 16h00, com pico de frequência às 13h00. Os dias analisados foram chuvosos pela manhã e nublados durante o resto do dia, proporcionando dias amenos em relação à temperatura. As abelhas africanizadas ficavam com o corpo repleto de pólen, transportando-o de uma flor para outra, realizando a polinização cruzada e beneficiando o processo de troca gênica entre as flores dessa espécie.



Nos dias de observação, as abelhas
M. scutellaris (uruçu nordestina) coletaram apenas néctar, entre 8h00 e 15h00. As abelhas X. frontalis (mamangava) se alimentaram de néctar; as abelhas T. spinipes (irapuás) e abelha da família Halictidae visitaram esporadicamente as flores do margaridão, para coleta de pólen. Os lepidópteros e os dípteros e os vespídeos se alimentaram, exclusivamente, de néctar, nas flores do margaridão, das 7h00 às 15h00.
De acordo com índice de constância, observou-se que os lepidópteros (73%) e as abelhas africanizadas (66%) foram espécies constantes, nas flores do margaridão. Já as abelhas M. scutellaris foram consideradas espécie acessória e as abelhas T. spinipes, abelhas halictídeas, abelhas X. frontalis, os vespídeos e os dípteros foram espécies consideradas acidentais.


Em função de fatores adversos como a degradação de áreas vegetais e a implantação de monoculturas, as espécies e as famílias de abelhas tem
entrado em declínio e a conservação desses importantes insetos depende da preservação da flora e alterações nos sistemas de produção. Por outro lado, houve crescimento no interesse dos agricultores familiares para a criação de abelhas, tanto as melíferas como as nativas sem ferrão, em função do valor econômico dos seus produtos, podendo ser uma fonte de renda importante para essas famílias. Entretanto, poucos conhecem quais as espécies vegetais disponíveis no decorrer do ano e qual recurso alimentar essas flores fornecem (néctar, pólen, resinas ou óleos).
Podemos concluir que o margaridão é visitado por diferentes espécies de insetos e que houve predominância das abelhas africanizadas, nas flores, em relação às nativas. Essa espécie vegetal deve ser plantada próxima à meliponários e apiários, sendo importante fonte de recursos alimentares para as abelhas, em especial em períodos de escassez de flora, por ser rústica e de rápido crescimento.
19 Pólen
Abelha mamangava Xylocopa frontalis coletando néctar, nas flores do margaridão (Thitonia diversifolia).
Borboleta (lepidóptero) se alimentando do néctar da flor do margaridão (Thitonia diversifolia).
Mosca (díptero) se alimentando de néctar na flor do margaridão (Thitonia diversifolia).
Vespa (vespídeo) se alimentando de néctar na flor do margaridão (Thitonia diversifolia).
Abelhas irapuás (Trigona spinipes) coletando pólen, nas flores do margaridão (Thitonia diversifolia).
Abelha da família Halictidae coletando pólen na flor do margaridão (Thitonia diversifolia).

LANÇAMENTO

TECNOBIO: O MAIOR EVENTO DE CONTROLE BIOLÓGICO DO BRASIL COMEMORA UMA DÉCADA DE EXISTÊNCIA

Ocontrole biológico é basicamente o uso de seres vivos para controlar a população de um outro ser vivo. Todos os seres vivos do planeta têm, não um, mas vários outros seres vivos (inimigos naturais ou agentes de biocontrole) que mantêm suas populações em equilíbrio. O primeiro uso desse fenômeno natural ocorreu na China antiga, por volta do século 3 a.C., onde os chi-









neses perceberam que onde havia as formigas predadoras Oecophylla smaragdina nos pomares cítricos, as pragas não causavam problema às produções de laranjas. Com isso, os chineses passaram a levar essas formigas de pomares onde estavam presentes para aqueles onde elas não existiam ou eram escassas.




De lá para cá, muitas observações
nesse sentido foram feitas por diferentes países, mas foi em 1888 que o controle biológico tomou um novo vulto, com a importação da joaninha Rodolia cardinalis da Austrália para os EUA, para o controle de cochonilhas dos pomares cítricos. Em 1889 essas pragas estavam controladas no Oeste americano e esse caso marca o controle biológico de pragas da era contemporânea.
22
Tecnobio
e
Importação
inoculação
Pequenas áreas . ambientes protegidos
Grandes áreas, auxílio a químicos
1889 2010 PERÍODO 1 PERÍODO 2 1960 PERÍODO 3 1990 PERÍODO 4 CONTROLE BIOLÓGICO APLICADO CONTROLE BIOLÓGICO CLÁSSICO E NATURAL
TEMPO Evolução do controle biológico na fase contemporânea.
Grandes áreas, igual aos químicos
LINHA DO
Por Dr. Alexandre de Sene Pinto Sócio e Consultor em Manejo Inteligente de Pragas da Occasio, Piracicaba, SP Professor da Agronomia do Centro Universitário Moura Lacerda, Ribeirão Preto, SP
No Brasil, as primeiras importações começam na década de 1920, para o controle de pragas das fruteiras, mas foi a cultura da cana-de-açúcar que mais avançou nessa tática de controle.
Na década de 1940, começaram a ser liberadas as moscas Billaea claripalpis e Lydella minense para o controle da broca-da-cana, Diatraea saccharalis, mas na década de 1970, a importação da vespinha Cotesia flavipes mudou a eficácia dessa tática de controle e passou a figurar como o maior programa de controle biológico do mundo.
No ano 2000, com a fundação da Bug agentes biológicos, uma “startup” que surgiu dentro da ESALQ/USP, na incubadora de empresas EsalqTec, em Piracicaba, SP, e com vários projetos PIPE (Pesquisa Inovativa em

Pequenas Empresas) aprovados em sequência pela Fapesp, foi ofereci-
O serviço de extensão agrícola é bem precário no Brasil, pois dentre vários problemas, menos de 10% dos profissionais das Ciências Agrárias têm esse tipo de formação. A divulgação do controle biológico sofre com isso, mas um evento como o Tecnobio, que começou em 2013, veio para fazer a diferença.
da ao agricultor mais uma opção de
controle da broca-da-cana, a microvespa Trichogramma galloi (parasitoide de ovos).
Com a disponibilização de Trichogramma galloi, depois de pesquisas desenvolvidas pelo Prof. Dr. José Roberto Postali Parra, ESALQ/USP, por 16 anos, e pelo Prof. Dr. Alexandre de Sene Pinto, Centro Universitário Moura Lacerda, por 15 anos, mais uma vez o controle biológico no Brasil mudou e iniciou uma nova fase.
Nessa fase 4 do controle biológico, não mais inimigos naturais sendo levados de uma região para outra (fase 1), nem sendo produzidos em fábricas e utilizados apenas em estufas ou em pequenas áreas (fase 2, que o mundo ainda está), mas passa-se a fazer em grandes áreas agrícolas (open fields), não somente para auxi-
23 Tecnobio
Parte frontal aberta do folder do primeiro evento Tecnobio, 2013.
Tecnobio
liar os inseticidas químicos sintéticos (fase 3), mas para igualá-los ou até superá-los em eficácia e em facilidade de uso.
Com tanta inovação e avanços, a divulgação do conhecimento gerado se tornou essencial, pois apenas por meio das revistas científicas a extensão agrícola não aconteceu, visto ser um meio de difícil compreensão para o agricultor brasileiro, e por só estar disponível a ele em 5 a 10 anos depois de criado. Nesse cenário surgem o Grupo de Pesquisa e Extensão em Controle Biológico (G.bio) (2006), que agora é Gebio, ligado a empresa Occasio e ao Centro Universitário Moura Lacerda, a revista de controle biológico G.bio (2010), que agora é Gebio (2022), e o evento de controle biológico Tecnobio.
O primeiro Tecnobio, chamado 1º Tecnobio PRAGAS, foi realizado em 20 e 21 de 2013, no Araucária Plaza, em Ribeirão Preto, SP, e teve palestras de várias culturas e de palestrantes
renomados, contando com o patrocínio de sete empresas/grupos. Foram 90 inscritos, naquela época.
Nos eventos, novas tecnologias foram apresentadas, como:



• o monitoramento da broca-da-cana com armadilhas de feromônio;
• as novas estratégias de monitoramento de todas as pragas da cana-de-açúcar, especialmente as de solo, e do milho, mais simples e precisas;
• a tecnologia de liberação de Trichogramma galloi e de Cotesia flavipes via drones específicos;
• a evolução dessas tecnologias aéreas (liberação de parasitoides sem cápsulas de proteção);
• o controle de adultos de Sphenophorus, especialmente com o fungo Beauveria bassiana;
• o manejo de adultos da broca-gigante, iniciada da AgroSerra (2012), desenvolvida na Pagrisa (2014) e ampliado o uso em Pedro Afonso (2020);
• o uso do fungo Cordyceps (=Isa-


ria) fumosorosea para o controle das mosca-branca, em soja, cigarrinha-do-milho, no milho, e da broca-da-cana e cigarrinhas, na cana-de-açúcar;
• o uso de Azospirillum brasilense em substituição ao nitrogênio químico de fertilizantes em cana-de-açúcar.
Foram muitas mudanças!

Em 2018, o Tecnobio passa a ser Tecnobio CANA, na sua sexta edição, e, em 2019, o primeiro evento regional é realizado em Lucas do Rio Verde, MT, Tecnobio GRÃOS, em 11 de setembro de 2019.








O Tecnobio mudou de espaço várias vezes por causa do número crescente de ouvintes. Começou com 90 e hoje reúne cerca de 450 participantes, de mais de 90 Usinas e fornecedores delas, empresas do setor e demais profissionais interessados no assunto, representando mais de 3 milhões de hectares de cana-de-açúcar. É um evento de sucesso!

24
EVENTO ONLINE 2020 2021 2013 2015 2017 2018 2019
2014 2016
Fotografias das edições 1 a 8 do Tecnobio.
MANEJO BIOLÓGICO EM CANAVIAIS: O QUE TEM DE NOVO?
Omanejo biológico do solo e de pragas e doenças do canavial vem crescendo e sendo aprimorado. São tantas inovações e novidades que fica difícil acompanhar tudo! São fungos, bactérias, nematoides entomopatogênicos e parasitoides de várias espécies sendo apresentados ao setor canavieiro.

Mas o agricultor precisa ficar atento às informações que recebe, se elas têm respaldo científico. Hoje tem muito “achismo” e oportunismo de gente que conhece superficialmente ou nada sobre esse universo que ainda não tem sido ensinado em Universidades e nem em Cursos Técnicos.
Para começar, produtos biológicos têm dose certa, nem muito menos, nem muito mais. Se usar muito mais do que a Ciência indica, não funciona. Como exemplo, Azospirillum bra-
silense, que numa concentração de 2x108 UFCs por mL de produto, se pretende disponibilizar nitrogênio para as plantas, tem que ser usado entre 200 e 600 mL do produto. Menos ou mais que isso, não funciona como deveria. O mesmo acontece para Trichogramma galloi, que para todas as possibilidades de infestação de ovos da broca-da-cana no Brasil, a dose recomendada pela Ciência é de 50.000 vespinhas por hectare. Se usar mais, pode nem controlar a broca-da-cana.
Os parasitoides que são usados em canaviais são seres vivos. Dentro de um recipiente, não podem ficar expostos ao calor exagerado, pois irão morrer e rapidamente. Ou pelo menos terão a eficácia comprometida. Também não podem sair de uma geladeira e serem levados direto para
o campo sem antes passar por uma sala climatizada por pelo menos uma hora.
Mas vamos lá! O que tem de novo no manejo biológico em canaviais?

O fungo Cordyceps (=Isaria) fumosorosea tem ganhado um espaço impressionante nos canaviais. Desde que ele foi lançado pela Koppert, para o controle de psilídeos na citricultura, logo passou a ser usado no controle de moscas-brancas em soja. Em 2021, o agricultor passa a seguir as minhas recomendações que faço desde 2018, que esse fungo deveria ser usado no controle de Dalbulus maidis, a cigarrinha-do-milho. E assim ele fez e o produto faltou no mercado esse ano, pois foi o melhor inseticida dentre todos, incluindo os químicos, no controle dessa terrível praga.
Mas foi em 2019 que as pesquisa de Caldeira (2019)1 e Silva (2019)2 indicaram que a broca-da-cana seria a próxima vítima desse fungo, que recebe o nome comercial de Octane pela Koppert. E assim foi, quando Garcia (2021)3 mostrou que Isaria tinha um período de ação em campo compatível com os químicos de “elite”.
Mais recentemente, Amorozo (2021)4 indicou ao agricultor a ação eficaz de Isaria no controle de ninfas pequenas e grandes e de adultos das cigarrinhas da cana-de-açúcar, dando uma ação bivalente ao fungo. Provavelmente, Isaria também controla Sphenophorus levis e já se sabe que é um bom controlador de cupins, fal-
25
Tecnobio
Por Dr. Alexandre de Sene Pinto Sócio e Consultor em Manejo Inteligente de Pragas da Occasio, Piracicaba, SP Professor da Agronomia do Centro Universitário Moura Lacerda, Ribeirão Preto, SP
Cotesia flavipes sobre lagarta da broca-da-cana
tando ainda entender como aplicar em solo para esse fim.
Falando em Sphenophorus, as iscas artificiais têm aumentado o interesse dos agricultores para a aplicação via drones para o controle de adultos. É uma estratégia simples e barata e esse ano será testada em grandes áreas para validar a tecnologia. Por enquanto, as novidades são os novos inseticidas químicos para o controle eficaz de ninfas pequenas e grandes, de forma terrestre ou aérea.
Os estudos do uso de inseticidas químicos e biológicos em vinhaça localizada avançam, onde alguns podem ser misturados à vinhaça e outros precisam ser aplicados em tanque separado, com vazão muito baixa, junto a vinhaça, por incompatibilidade com a vinhaça ou por não terem sido estudados ainda.
Em 2022, os bionematicidas superaram os nematicidas químicos em área aplicada no Brasil. Todos os produtos lançados pelas empresas-referência são eficazes no controle de nematoides e apresentam ações secundárias muito interessantes que devem ser exploradas.
Para as cigarrinhas, o óleo de neem misturado a produtos do próprio óleo passa a figurar entre as opções sustentáveis e entre os produtos para serem usados em áreas de restrição. Mas novos inseticidas químicos foram lançados e estão sendo bem utilizados para essa praga.
A broca-da-cana está sendo muito bem manejada com muitas opções de controle, mas além do fungo Isaria, Beauveria bassiana também tem mostrado bom controle. Este último tem sido aplicado para o controle de adultos de Sphenophorus nas chuvas (duas aplicações, normalmente uma em novembro e outra em janeiro).
Trichogramma galloi é o biológico de “elite” e além da liberação de uma série de 3 (semanais), com 60 dias de período de ação, agora também tem sido feito numa série de 5 (semanais), com período de 120 dias! E pesquisas bem atuais indicam que a liberação de Trichogramma em faixas de 90 metros (diferente das faixa de 30 m atuais) ou apenas em bordaduras de talhões, via drone, apesar de demorar mais para controlar, parece oferecer um período de ação mais eficaz e
prolongado.
A vespinha Cotesia flavipes tem perdido seu espaço como tática principal de manejo, mas tem ganhado destaque como complementar para variedades suscetíveis à broca ou para cana-planta, em áreas de restrição e para o período da seca. É um parasitoide insubstituível.


E Bacillus thuringiensis é uma boa opção para baixas infestações da broca-da-cana, para evitar coração-morto em plantas em início de desenvolvimento e para áreas de restrição.
Um dos lançamentos mais esperados é a dos nematoides entomopatogênicos para o controle da maioria das pragas de solo. Apesar do registro desses produtos ser para Sphenophorus, que terá eficácia superior a 80%, o que se espera para migdolus é um controle superior a 90% dos ovos e das larvas.
São muitas novidades e muitas outras estão por vir. Que bom que temos o Tecnobio para nos atualizar sempre sobre tudo isso que está acontecendo. Parabéns, Tecnobio, pelos seus 10 anos de existência!!
Fungo Metarhizium anisopliae infectando ninfa da cigarrinha-das-raízes Trichogramma galloi sobre ovo da broca-da-cana
1 CALDEIRA, G.A.M.R. Efeito ovicida de inseticidas químicos e biológicos sobre Diatraea saccharalis em laboratório. 2019. 36f. Monografia (Trabalho de Conclusão de Curso de Agronomia) – Centro Universitário Moura Lacerda, Ribeirão Preto, 2019
2 SILVA, F.R. da. Isaria fumosorosea no controle de ovos e lagartas neonatas de Diatraea saccharalis (Fabr.) (Lepidoptera: Crambidae). 2019. 40f. Trabalho de Conclusão de Curso (Graduação em Agronomia) – Centro Universitário Moura Lacerda, Ribeirão Preto, 2019
3 GARCIA, L.O.E. Eficácia e período de ação de inseticidas químicos e biológicos no controle da broca-da-cana, Diatraea saccharalis, em cana-de-açúcar. 2021. 42f. Trabalho de Conclusão de Curso (Graduação em Agronomia) – Centro Universitário Moura Lacerda, Ribeirão Preto, 2021.
4 AMOROZO, T.S. Controle microbiano das cigarrinhas-das-raízes utilizando Metarhizium anisopliae e Cordyceps fumosorosea em cana-de-açúcar. 2021. 24f. Trabalho de Conclusão de Curso (Graduação em Agronomia) – Centro Universitário Moura Lacerda, Ribeirão Preto, 2021
26 Tecnobio
O ESTADO DA ARTE DO CONTROLE BIOLÓGICO NO BRASIL
Por Dr. José Roberto Postali Parra Departamento de Entomologia

OBrasil, hoje, se coloca entre os grandes usuários do Controle Biológico no mundo, seja de microrganismos ou de macrorganismos. Atualmente, o Controle Biológico passou a ser visto não só como uma atividade de controle de pragas, mas também relacionado aos bioagentes, biofertilizantes e bioestimulantes. São os bioinsumos, que podem ser definidos como “produtos ou processos agroindustriais desenvolvidos a partir de enzimas, extratos (de plan-
tas ou de microrganismos), microrganismos, macrorganismos (invertebrados), metabólitos secundários e feromônios destinados ao Controle Biológico”.

Na verdade, hoje existem no Brasil mais de 500 produtos disponíveis no mercado, segundo a Croplife, com mais de 56 produtos biológicos registrados apenas em 2020. E uma receita de 1,8 bilhão de reais e mais de 20 milhões de ha tratados com bioló-
gicos para a proteção de pragas. Enquanto a utilização do Controle Biológico aumenta na ordem de 10-15% ao ano no mundo, no Brasil este aumento é de 30% ou mais, desde 2018. É conveniente lembrar que o país tem grandes áreas plantadas, com sucessão de culturas, 2 a 3 safras ao ano e isto é diferente de locais tradicionais na utilização de Controle Biológico, como nos países da Europa. Nos países europeus, as áreas plantadas são menores e usa-se muito con-
27 Tecnobio
Shutterstock
e Acarologia, ESALQ/USP, Piracicaba, SP
Tecnobio
trole biológico em casas-de-vegetação; no Brasil temos os chamados “campos abertos” (open fields) com áreas enormes, existindo agricultores com 20.000, 50.000, 100.000 hectares plantados, com uma única cultura e com um agricultor como dono da propriedade.
Nos últimos anos, houve uma grande corrida para transformar o país num “modelo de Controle Biológico para regiões tropicais”, assim como é líder mundial na Agricultura Tropical, com o Agronegócio brasileiro representando 30% do PIB nacional.
Existem mitos a serem desmistificados, como o “cultural” em que o agricultor acostumado por gerações com agroquímicos, insiste na sua manutenção como único meio de controle. Isto começou a mudar em 2013, quando foi registrada a praga Helicoverpa armigera no Brasil Central. Praga com mais de 250 hospedeiros, não tinha, à época, produtos químicos registrados. Utilizaram para controlar a praga, o vírus específico e
Trichogramma pretiosum, um parasitoide de ovos. Este, pode ser considerado, o grande marco do Controle Biológico no país. Com resultados espetaculares de controle, o agricultor passou a utilizar mais o Controle Biológico.

Um outro mito, é que o Controle Biológico é “fácil” de ser feito. Se for assim considerado, torna-se um processo amador e não profissional como deve ser. Os produtos biológicos, sejam macro ou microrganismos, têm que ter qualidade, independente do tamanho da fábrica que os esteja produzindo, no caso de controle de pragas. O profissionalismo é fundamental para que não seja denegrida a imagem do Controle Biológico nesta fase de “aumento de utilização”.
Atualmente, grandes empresas têm o seu portfólio de produtos biológicos disponíveis ao agricultor, garantindo a qualidade de tais produtos. As pequenas empresas, muitas delas “startups”, com produções menores, também devem se preocupar com
a qualidade, neste momento de implantação do Controle Biológico no Brasil. São cerca de 140 empresas registradas com produtos biológicos.
Outros mitos devem ser desmistificados, como o “custo” (que ainda acham que tem que ser mais barato do que os químicos, sem se preocupar com as vantagens ecológicas e sociais) e julgam (erroneamente) que se trata de uma medida de controle a “longo prazo” e que o Controle Biológico deve “resolver tudo sozinho”, sem se lembrar que a filosofia atual é a de MIP (Manejo Integrado de Pragas).
Aumentou bastante a massa crítica no país de especialistas em Controle Biológico, especialmente com os 50 anos de Pós-Graduação no Brasil, que permitiram a formação de muita gente no assunto e o aumento do investimento, com Institutos ou Centros de Controle Biológico, como Embrapii, na ESALQ, Bioinsumos na Embrapa e SPARCBio também na ESALQ, este último financiado pela
28
Ovos de Spodoptera frugiperda sendo parasitados por Trichogramma pretiosum
FAPESP, KOPPERT e USP e coordenado pelo autor deste artigo, atualmente contando com cerca de 60-70 pesquisadores trabalhando no assunto.
Temos desafios, como disponibilidade de agentes de controle biológico, principalmente de macrorganismos, com qualidade adequada e transferência de tecnologia ao usuário (os serviços de extensão são ainda carentes, para um assunto que ainda muitos desconhecem), momento adequado de liberação e problemas de logística, de armazenamento e transporte para um país continental como o Brasil.
Um dos problemas apontado na publicação de 20141, na Revista Ciência Agrícola, a liberação de inimigos naturais foi sanado, pois hoje mais de 95% dos inimigos naturais em cana-de-açúcar são liberados com drones. A Entomologia moderna se utiliza muito da Agricultura 4.0 e esta foi uma das soluções, ao lado da amostragem para liberação que começa a ser estudada mais profundamente, ao lado de uma legislação própria para o Controle Biológico que começa a ser mais discutida e já muito mais ágil do que há alguns anos.
O Controle Biológico caminha bem, com milhões de ha tratados com microrganismos (cerca de 80% da área) e macrorganismos (com cerca de 20% da área).
Por que esta diferença? Os microrganismos se assemelham mais aos químicos em sua aplicação e têm o chamado “tempo de prateleira” (shelf life), às vezes, por alguns meses; os macrorganismos têm que ser utilizados imediatamente após a produção e muitas vezes se perdem no caminho. Além disso são exigidas produções massais para criação de milhões de insetos e ácaros, produção que começa a ser automatizada, por terem
na mão-de-obra, de 70-80% do custo total da produção. Assim, para liberação de um agente de Controle Biológico, são necessários alguns anos de estudo. Trichogramma galloi desenvolvido pelo grupo de pesquisa da ESALQ/Departamento de Entomologia e Acarologia, demorou 16 anos para ser oferecido para o agricultor (1984-2000) e hoje é aplicado em al-
guns milhões de hectares.
Assim, o Controle Biológico caminha a passos largos no Brasil, crescendo mais do que no resto do mundo e sendo um componente fundamental nos programas de Agricultura Sustentável, para um país, em que o Agronegócio é o sustentáculo da economia nos dias de hoje.

29 Tecnobio
1 PARRA, J.R.P. Biological Control in Brasil: an overview. Scientia Agricola, v.71, n.5, p.420-429, 2014
Ovos de Diatraea saccharalis parasitados por Trichogramma galloi
A MICROBIOLOGIA NA NUTRIÇÃO DE CANAVIAIS

Aagricultura vive um momento de redefinição nas formas de nutrir adequadamente as plantas cultivadas. Este momento se desenha pela necessidade financeira, definida pela alta dos preços de fertilizantes, e pelo maior conhecimento e exploração de outros processos
relacionados a nutrição vegetal. Dentro deste tema, existe a busca para o melhor uso de recursos microbianos na nutrição das plantas cultivadas. Este tema dá origem a principal pergunta feita pelos agricultores neste momento: “Como podemos utilizar a microbiologia num sistema me-
nos dependente de fertilizantes?” Esperamos responder parte desta pergunta ao final deste texto, após compreendermos melhor alguns conceitos relacionados ao tema.
A biodiversidade microbiana que reside no solo, e dá a este ambiente a capacidade de suportar o desenvol-
Fontes de nutrientes para as plantas cultivadas. 1MOS: matéria orgânica do solo.

30
Tecnobio
Extração pelas plantas Formas solúveis no solo Fertilizantes (orgânicos/minerais) Atividade biológica (disponibilização)
Mineralização da MOS 1
Por Dr. Fernando Dini Andreote Departamento de Ciência de Solo, ESALQ/USP, Piracicaba, SP
MSc. Alessandra Rigotto Andrios Assessoria e Treinamento Técnico-científico em Microbiologia, Piracicaba, SP
Extração pelas plantas
Estoque P inorgânico Estoque P orgânico
• P-argilas
• P-Ca, P-Fe, P-Al
• P-minerais
ácidos (orgânicos/ inorgânicos)
vimento vegetal, é capaz de atuar de diversas formas na disponibilização de nutrientes para as plantas. Devido as capacidades encontradas dentre os milhares de espécies de micro-organismos presentes nesta interface solo-planta, podemos, por exemplo, encontrar atividades que disponibilizam nitrogênio e fósforo para as plantas. Vamos analisar estes dois casos em um pouco mais de detalhes dentro do sistema de cultivo de cana-de-açúcar.
O nitrogênio é abundante no solo sob a forma gasosa (N2), sendo a fixação biológica deste elemento, transformando-o em amônia (NH3) um dos processos biológicos mais conhecidos na agricultura, a FBN (fixação
Micorrizas arbusculares (captura de formas solúveis e transporte para as plantas)
• fitato
• inositol
• membranas
• ácidos nucléicos
enzimas (fosfatases/ fitases)
biológica do nitrogênio). Associado a cana-de-açúcar, diferentes bactérias podem atuar neste processo, colonizado desde o ambiente rizosférico até os tecidos internos das plantas. Na rizosfera, o ambiente rico em exsudatos, com alta disponibilidade energética (principalmente por carbono assimilável), e baixas tensões de O2 promovem esta atividade. Já nos tecidos internos das plantas, as bactérias endofíticas são as responsáveis por esta atividade. Apesar de alguns grupos bacterianos serem conhecidos por este potencial, como Azospirillum brasilense, Nitrospirillum amazonense, Gluconacetobacter diazotrophicus e Herbaspirillum seropedicae, diversos grupos bacterianos podem atuar nesta importante
funcionalidade para a nutrição nitrogenada das plantas. É importante destacar neste ponto, a necessidade da disponibilidade de molibdênio (Mo) para a eficiente ocorrência deste processo, sendo este um componente do complexo da nitrogenase, molécula que captura o N2, e o converte em formas amoniacais.
Em relação ao fósforo (P), existem diversos processos relacionados com a disponibilização deste elemento para as plantas. Basicamente, podem existir nos solos, dois reservatórios de fósforo, os quais podem ser ao menos parcialmente explorados e disponibilizados para as plantas. O estoque de P inorgânico é composto de formas deste elemento ligada
31 Tecnobio
Formas solúveis de P H2PO4- / HPO4-2
A biodiversidade como promotora de processos na nutrição de cana-de-açúcar com fósforo.
a óxidos de Fe, Al e Ca (dependendo do pH do solo), além de P associado a argilas e a minerais primários. Por meio da atividade biológica, algumas destas formas podem ser convertidas em P solúvel por meio da atividade de ácidos orgânicos ou inorgânicos, produzidos e secretados por diversos fungos e bactérias durante seus respectivos metabolismos. Este processo é bastante diversificado e principalmente induzido pela disponibilidade de energia (a rizosfera é um exemplo deste ambiente). Outra reserva que pode estar presente no solo está sob a forma de P orgânico, onde tem destaque compostos como o fitato e o inositol (além de outras moléculas em menores quantidades). As formas orgânicas de P podem ser convertidas em formas solúveis por meio da atividade de enzimas, como as fitases e fosfatases, as quais clivam os radicais fosfáticos presentes em matrizes orgânicas. Em conjunto, observa-se que podem ocorrer nos solos dois grandes reservatórios de P, sendo as chaves para exploração dos mesmos representadas por processos microbianos. Voltando estas referências para o cultivo da cana-de-açúcar, podemos inferir sobre o reservatório de P inorgânico como resultante do uso de fertilizantes fosfatados, e o estoque de P orgânico como reflexo direto do conteúdo de matéria orgânica no solo, ou do uso de torta de filtro como adubação orgânica. No entanto, pode-se analiticamente determinar estas quantidades numa análise detalhada sob as formas de P presentes nos solos.
Por fim, é essencial falarmos sobre micorrizas quando comentamos sobre processos biológicos e disponibilidade de P para as plantas. Apesar deste tema merecer um texto a parte, deve ficar claro o papel de micorrizas arbusculares na cana-de-açúcar, atuando na captação não apenas de P, mas de outros nutrientes, em formas solúveis, e transporte destes elementos para o interior das plantas. Numa visão mais abrangente, sabe-se que
as micorrizas atuam não apenas na nutrição das plantas, mas servem também como um sistema eficiente de comunicação entre plantas, ainda a ser mais bem explorado no contexto da agricultura.
Vale lembrar que outros nutrientes podem também ser disponibilizados para a cana-de-açúcar por meio da atividade microbiana, como por exemplo, nos processos de solubilização do potássio, ou de oxidação do enxofre elementar. Assim, a visão da biodiversidade do solo se reflete diretamente na dinâmica nutricional na interface solo-planta, resultando na contribuição da microbiologia do solo para suprir as demandas vegetais.
Retomando o questionamento apresentado no início do texto, haveria então a chance de usar estes processos para a nutrição das plantas em substituição aos fertilizantes? A resposta é bastante conhecida: Depende! Ao observarmos que as plantas obtêm sua nutrição de diferentes fontes (ver figura), esta resposta seria esperada, sendo toda generalização neste tema bastante passível de erro, e consequente ineficiência na nutrição das plantas cultivadas. Os valores de contribuição dos processos biológi-
cos para a nutrição da cana-de-açúcar devem ser determinados experimentalmente, e dentro de cada um dos ambientes de produção da cana-de-açúcar. São fatores interferentes na determinação destes valores o solo empregado para o cultivo (mais do que textura, pedologia e conservação são importantes), a qualidade biológica do solo (representando a capacidade de realizar as atividades desejadas), e a demanda da cultura (diferenciada deste o plantio até as diferentes rebrotas).
Certamente, muitos avanços deverão ser atingidos dentro desta temática num futuro próximo, auxiliando no uso mais assertivo de recursos microbianos para a eficiente nutrição das plantas. Permeiam as inovações as estratégias de manejo que promovem a biodiversidade e a atividade microbiana nas áreas de cultivo, bem como o desenvolvimento de bioinsumos com as diversas características que contribuem para disponibilização de nutrientes para a cana-de-açúcar. É evidente, portanto, a participação da microbiologia na montagem de sistemas de nutrição mais eficientes, contribuindo como sólido pilar de inovação no manejo e na eficiência no cultivo da cana-de-açúcar.

32
Tecnobio Shutterstock
CONTROLE DE CUPINS E FORMIGAS NA CANA-DE-AÇÚCAR
Por Dr. José Eduardo Marcondes de Almeida Pesquisador Científico do Instituto Biológico (APTA/SAA)
CUPINS
A cana-de-açúcar é uma das principais culturas do Brasil, chegando a 10 milhões de hectares de área plantada, sendo só no Estado de São Paulo de aproximadamente 6,5 milhões de hectares. A produtividade poderia ser maior se não fosse pelos prejuízos causados por pragas, sendo os cupins uma das mais importantes, principalmente a espécie Heterotermes tenuis, pois é a mais freqüente e de maior distribuição, sendo que os danos atingem a 10 toneladas por hectare por ano.
O manejo através do levantamento de espécies e população em áreas de reforma de cana, o uso racional

de inseticidas químicos e a melhoria do teor de matéria orgânica no solo, produz uma condição mais adequada para o controle e a convivência da cultura com essas pragas.
Bioecologia
A principal família dos cupins-praga é a Rhinotermitidae, sendo que a espécie mais importante do Brasil é Heterotermes tenuis. Essa espécie é a mais comumente encontrada na cultura da cana, causando o maior prejuízo devido ao seu hábito subterrâneo, atacando as raízes da planta e chegando ao colmo. Seu ninho é difuso e possui grande capacidade de adaptação ao agroecossistema
da cana, já que se trata de uma cultura semiperene, com renovação do canavial após cada 5 anos, ou seja, as operações de aração, gradagem, subsolagem, sulcamento, calagem e adubação são realizadas a cada período de 5 anos, destruindo grande parte das galerias desta espécie de cupim, porém não destrói os ninhos com a respectiva rainha, permitindo novos ataques quando ocorre o novo plantio da cana.
Os danos na cana são causados em três períodos: a) logo após o plantio, nas gemas dos toletes da cana-planta; b) no início do crescimento e perfilhamento, causando injúrias e c) após o corte, quando as soqueiras ficam vulneráveis devido ao “stress”.
33 Shutterstock Tecnobio
34 Tecnobio
Os danos podem ser reconhecidos por falhas de germinação, em reboleiras, galerias nos toletes e presença de fezes próximo às soqueiras.
Monitoramento
O monitoramento de cupins na cana deve ser realizado após a última colheita, antes da reforma da área, adotando os seguintes procedimentos:
a) Levantamento nas soqueiras: deve-se realizar a avaliação de soqueira de cana em dois a quatro pontos por hectare, retirando-se a touceira de cana e cavando-se uma trincheira de 50 x 50 x 50 cm. Avalia-se o número de espécies de cupins e a população de cupins através da escala: 0 – ausência de cupins; 1 – 1 a 10 insetos; 2 – 11 a 100 insetos e 3 – mais de 100 insetos.

b) Levantamento com iscas Termitrap: deve-se instalar 20 iscas por hectare, eqüidistantes ou em caminhamento diagonal na área, marcadas com estacas de bambu, após a colheita da cana do canavial a ser reformado. Após 15 dias, avalia-se as iscas com a escala de notas igual à utilizada para o levantamento nas soqueiras. A isca Termitrap permitiu realizar um levantamento de espécies de cupins na região de Piracicaba, SP durante três anos, sendo que a espécie mais atraída foi H. tenuis, porém foi possível coletar ainda as espécies: Cornitermes cumulans, Procornitermes spp., Nasutitermes spp., Anoplotermes spp., Constrictotermes spp., Ruptitermes spp., Syntermes molestus, Cylindrotermes sp., Neocapritermes spp. e Coptotermes havilandi. Os danos nas raízes da cana foram associados à H. tenuis e Procornitermes sp.

A isca Termitrap foi desenvolvida na ESALQ/USP, Piracicaba, SP, a partir de testes de materiais atrativos à H. tenuis em laboratório e campo. O papelão corrugado foi o mais atrativo, sendo então utilizado na confecção de iscas para estudos de levantamento de cupins em cana, flutuação
 Morte de perfilho de cana-de-açúcar causada por cupins subterrâneos.
Soldado de Heterotermes tenuis
Ataque de Heterotermes tenuis em rizoma de cana-de-açúcar.
Morte de perfilho de cana-de-açúcar causada por cupins subterrâneos.
Soldado de Heterotermes tenuis
Ataque de Heterotermes tenuis em rizoma de cana-de-açúcar.
populacional e controle.
Deve-se realizar o controle químico quando houver mais de 30% de pontos infestados com cupins pelo levantamento populacional em soqueiras ou mais de 20% com as iscas Termitrap.
Controle químico
O controle químico geralmente é feito com aplicação em área total, pulverizando o solo no momento do preparo dos sulcos para o plantio.
Inseticidas recomendados:
• Fipronil (Regent 800 WG): 250 a 500 g ha-1;
• Tiametoxam (Actara 250 WG): 400 a 800 g ha-1.

Controle biológico e iscas

As iscas para cupins subterrâneos possuem um potencial grande de utilização, pois são capazes de atrair grandes quantidades de insetos, utilizam os aspectos de biologia, comportamento de trofalaxia e tunelamento dos cupins e ainda podem levar um agente químico ou biológico para dentro da colônia, disseminando-o e eliminando a rainha e o ninho do cupim, além de se constituir em uma alternativa barata e ecológica.
Assim, o emprego de iscas, que utiliza em favor do controle o comportamento social dos cupins, como trofalaxia, grooming e tigmotropismo, têm surgido como alternativa viável. Dessa maneira, a utilização de isolados selecionados dos fungos Beauveria bassiana e Metarhizium anisopliae é uma alternativa viável. Esses entomopatógenos encontram condições favoráveis de temperatura e umidade nas colônias dos cupins. Os fungos são impregnados na forma de conídios em iscas atrativas tipo Termitrap, já desenvolvida para o monitoramento e controle em cana-de-açúcar e florestas. Trata-se, por-

35 Tecnobio
Ataque de Heterotermes tenuis em colmos de cana-de-açúcar.
Atta laevigata
Isca Termitrap® com soldados de operários de Heterotermes tenuis
Tecnobio
migas formam grandes quantidades de formigueiros isolados e chegam a raspar o solo das pastagens.
Formigas saúvas (Atta capiguara e Atta bisphaerica)
Fazem parte do grupo das formigas cortadeiras chamadas saúvas. Seus ninhos são grandes, com grande população e a dimensão do corpo é maior que o da formiga quenquém.
A espécie Atta capiguara - saúva parda ataca especialmente as gramíneas, sendo que o seu ninho é um murundum de terra fora da projeção da panela ativa, diferente das demais espécies, cujos montes de terra estão sobre a panela de fungo. É menos agressiva que as outras, mas suas operárias trabalham mesmo com o tempo fechado e temperatura baixa.
Atta bisphaerica, conhecida como saúva mata-pasto, tem os soldados parecidos com A. capiguara, porém sua cabeça é mais pontiaguda e tem um sulco mais profundo. Seus ninhos possuem um monte de terra solta, sem crateras, com olheiros de aberturas estreitas na sua superfície. Essa espécie corta: arroz, cana-de-açúcar, capins e milho.
tanto, de uma introdução inoculativa do patógeno na colônia, podendo ser usado em associação com um inseticida ou regulador de crescimento em subdosagem.
FORMIGAS CORTADEIRAS
As formigas cortadeiras são importantes pragas da cana-de-açúcar, visto que cortam grande quantidade de folhas, causando a diminuição da massa verde e chegando a matar a touceira. Esses insetos possuem colônias divididas em castas no subsolo. As castas são as seguintes: rainha, responsável pela organização e re-
produção da colônia; operárias, fazem todo o trabalho de corte e transporte de folhas, além da limpeza do ninho; jardineiras são operárias menores, responsáveis pelo cultivo do fungo que vai alimentar toda a colônia e soldados que são mais robustos e fazem a defesa da colônia.
Formiga quenquém (Acromyrmex sp.)

A formiga quenquém forma ninho pequeno, com população menor que as saúvas, porém são importantes pragas das pastagens, principalmente a espécie Acromyrmex landolti balzani, “formiga de raspa” ou “formiga boca de capim”. Estas for-
Atta laevigata, saúva-de-vidro ou saúva cabeça-de-vidro. Os soldados possuem cabeça grande, com brilho semelhante ao vidro. Seu formigueiro apresenta terra solta, sobre a sede real, com olheiros que se abrem diretamente ao nível da terra solta e servem para retirar partículas de terra para o exterior quanto à entrada de material cortado. Ataca: milho, capins e florestas.
Atta sexdens rubropilosa, saúva limão. A cabeça do soldado é opaca, com muitos pelos. É comumente encontrada atacando capins, milho e cana-de-açúcar.
Até hoje, não se conseguiu medir os danos, em termos de porcentagens, pois a determinação dos danos é muito complicada.
36
Controle
Iscas granuladas
As iscas granuladas são a base de bagaço de laranja, impregnado com o inseticida sulfluramida. Esse inseticida tem ação letal sobre as jardineiras e operárias, matando o formigueiro de forma lenta, mas eficaz.
Para a aplicação de iscas granuladas é importante fazer uma avaliação da infestação, ou seja, o número de formigueiros existentes na área, bem como identificar se é saúva parda ou mata-pasto, pois no caso de saúva parda, o cálculo do tamanho da área do formigueiro é diferente. Enquanto para as outras saúvas o cálculo é feito medindo-se a maior largura pelo maior comprimento do murundum, através de passadas largas de aproximadamente 1 metro, para a saúva parda a área é calculada medindo-se o maior comprimento pela maior largura do retângulo formado pelo monte de terra solta, mais a área de montículos menores e seus olheiros. As iscas formicidas deverão ser colocadas nesta área.
A dosagem recomendada é de 10 g de iscas/m2 de sauveiro, sendo aconselhável a aplicação em época seca, de preferência com o solo seco.
Deve-se levar em conta algumas re-
Tecnobio
migueiro e especialmente indicada para locais com grandes quantidades de formigueiro.
comendações:
• Para saúva mata-pasto deve-se usar 20% menos de inseticida
• Para saúva parda, se a quantidade de sauveiros for maior que 13 por hectare, é importante fazer aração e gradagem (reforma do pasto), mantendo o terreno limpo de vegetais durante 120 dias.
• Para quenquém, pode-se utilizar iscas atrativas, idem a saúvas.
• Não manusear as iscas com a mão nua, pois além do risco de contaminação do aplicador, o cheio humano impede de a saúva carregar as iscas.
• Não aplicar iscas granuladas dentro do olheiro, pois as formigas vão retirá-las, perdendo-se o efeito.
Termonebulização
A termonebulização é um método mais rápido, porém com alguns inconvenientes, tais como a degradação do inseticida devido a alta temperatura e problemas mecânicos com o aparelho, além de ser necessário localizar cada olheiro.
As principais vantagens da termonebulização são: rapidez, pode ser utilizada em qualquer época do ano, em qualquer tipo de terreno, consumir pouco formicida por formigueiro, não ser necessária a medição do for-
O termonebulizador deve ser operado corretamente para que possa apresentar bons resultados. Após ligar o motor, deve-se esperar esquentar o queimador, colocar a ponta do cano aplicador na entrada do lheiro e abrir a torneira dosadora do formicida, fechando-a assim que começar a sair uma fumaça branca e densa. A torneira deve ser aberta e fechada sempre que houver diminuição da densidade da fumaça. Todos os olheiros que saírem fumaça devem ser tapados, até que todo o formigueiro seja aplicado, sendo que o olheiro de aplicação deve ser tapado após a retirada do cano de aplicação. O termonebuizador deve ser trocado de lugar no caso de algum olheiro não emitir fumaça.
Os inseticidas mais usados são clorpirifós e fenitrotiom.
Pós secos
Existem no mercado inseticidas em pó finíssimo que podem ser aplicados com uma polvilhadeira manual. Um dos produtos mais aplicados é a deltametrina.
Esta técnica não deve ser utilizada em formigueiros grandes.
Controle biológico
As formigas cortadeiras possuem inimigos naturais, tais como mosquitos da família Phoridae, que parasitam as formigas na entrada ou saída do formigueiro.
Além disso, os fungos Beauveria bassiana e Metarhizium anisopliae e nematóides do gênero Steinernema infectam as formigas cortadeiras, porém os resultados positivos de controle só foram conseguidos até o momento em laboratório.

37
Shutterstock
POR QUE USAR TRICHODERMA?
Trichoderma é um fungo que existe há mais de 100 milhões de anos, porém só se tornou alvo do interesse científico no final dos anos 70. Durante a segunda guerra mundial, notaram que o algodão das tendas e roupas dos soldados estava sendo deteriorado por um fungo verde que foi coletado e estudado, recebendo o nome de Trichoderma viride. Mais
tarde foi descoberta a excepcional capacidade de produção de enzimas celulolíticas, e então Trichoderma passou a ser utilizado na indústria de enzimas.
Muito tempo depois as demais habilidades de Trichoderma foram reveladas e esse fungo passou a ser empregado na agricultura. Inicialmente
era utilizado somente como fungicida biológico pois eles conseguem parasitar outros fungos e exercer um excelente controle de doenças. Hoje sabe-se que Trichoderma pode ofertar outras melhorias para diversas culturas de interesse econômico. Dentre os principais benefícios que Trichoderma pode trazer para plantas estão o biocontrole de diversas doenças de solo e parte aérea, a promoção de crescimento e a indução de resistência contra diversos patógenos.

No biocontrole de doenças Trichoderma têm demonstrado excelente atividade contra mofo branco, podridão radicular, requeima e algumas nematoses. É um fungo que apresenta diversos mecanismos de ação contra os fitopatógenos. Pode agir de forma direta parasitando e matando outros fungos ou suprimindo o desenvolvimento dos microrganismos prejudiciais por competir por espaço e nutrientes presentes no meio ambiente. Além disso, pode produzir e liberar mais de 100 tipos de compostos que podem ser tóxicos para os patógenos e nematoides do solo.

Outra forma de controle que é bastante relatada é a indução de resistência que esse fungo pode causar nas plantas. Trichoderma consegue se comunicar com as plantas pelo sistema radicular. Após colonizar as raízes, planta e fungo começam a se relacionar de forma a se ajudarem mutuamente.
Quando a colonização ocorre o fungo adentra pelas camadas das raízes crescendo internamente até certo ponto e essa invasão sinaliza para a planta a presença de um “intruso”. Com esse aviso a planta começa a liberar muitos compostos que vão ajudá-la a se proteger de ataques de agentes causadores de doenças. Dessa forma, é como se Trichoderma funcionasse como um tipo de “vacina” contra diversos tipos de fitopatógenos, pois no momento da infecção
38 Tecnobio
Hifa de Trichoderma (seta verde) enovelada sobre hifa de Rhizoctonia solani (seta vermelha) no início do processo de parasitismo.
Por Dra. Patricia Elias Haddad Bióloga Itatijuca Biotech e Instituto Biológico
a planta estará com suas defesas ativadas para combater os invasores, diminuindo os prejuízos do ataque.
Na indução de resistência toda a planta é afetada, ou seja, a inoculação de Trichoderma é via radicular, porém observa-se resistência também para os patógenos da parte aérea, onde é obtida uma proteção completa que possibilita a diminuição dos sintomas de qualquer tipo de patógeno ou praga.
Além de cooperar para controlar as doenças e pragas, Trichoderma tem se revelado um ótimo promotor de crescimento de várias culturas agrícolas. Quando o fungo se associa com a planta ele pode aumentar o sistema radicular fazendo com que a absorção de água e nutrientes de solo seja mais eficiente, refletindo
em aumento da parte aérea que por sua vez favorece a produtividade. Além disso, o uso de Trichoderma também aumenta a quantidade de pelos radiculares e raízes laterais, favorecendo um maior alcance para a planta utilizar os elementos do solo para seu crescimento.

Diversos estudos têm demonstrado que algumas linhagens de Trichoderma podem solubilizar e disponibilizar muitos nutrientes do solo como fosfato de rocha, ferro, zinco, manganês para as plantas, contribuindo para o crescimento principalmente em solo mais pobres, onde a condição nutricional pode ser limitante para a cultura.
Outra vantagem do uso de Trichoderma é que muitas linhagens apresentam compatibilidade com produ-
tos químicos, fato que as torna muito funcionais para aplicação no manejo integrado. Enquanto outras, tem potencial para degradar compostos xenobióticos do solo, fazendo um trabalho de bioregeneração onde é possível recuperar o solo danificado.
Portanto, quando aplicado na dosagem correta, a utilização de Trichoderma pode colaborar para um cultivo mais sadio, produtivo e sustentável, podendo ser utilizado dentro do manejo integrado de diversas culturas aumentando a produtividade, diminuindo o uso de fertilizantes e outros insumos químicos, reduzindo a população de patógenos de solo e nematoides, e tornando a planta mais resistente aos estresses bióticos e abióticos.
39 Tecnobio
Sistema radicular de cana-de-açúcar sem microrganismos inoculados (A), inoculado com o nematoide Meloidogyne javanica (B), e inoculado com M. javanica e tratada com Trichoderma (C).
MANEJO BIOLÓGICO ACELERA DESENVOLVIMENTO E REDUZ PERDAS NO CANAVIAL
ABP Bunge Bioenergia, empresa formada pela joint venture das operações de açúcar e etanol da BP e da Bunge, tem projetos em curso para ampliar a aplicação de biológicos nos canaviais, em larga escala. As ações auxiliam a planta a atingir seu máximo potencial genético, diminuem riscos de perdas e garantem altas produções.
O manejo biológico é realidade em 100% das nossas áreas, com resultados comprovados de eficiência, seja na atuação preventiva e no controle de pragas e doenças, como também na renovação da biota do solo, tra-

zendo benefícios de solubilização e melhor absorção de nutrientes, assim como estímulo de produção de hormônios fundamentais para o desenvolvimento do canavial. Nesta safra, a aplicação de produtos biológicos nas nossas áreas, variando com a necessidade, será equivalente a mais de 1 milhão de hectares tratados com bioinsumos.
Pragas e doenças
A BP Bunge adota o controle de nematoides em sua totalidade com bioinsumos, não sendo necessário a complementação de produtos quí-
micos, garantindo eficiência similar ou até superior em alguns casos. Para a cigarrinha-das-raízes (Mahanarva spp.), utilizamos o fungo Metarhizium anisopliae nas áreas onde temos a infestação da praga. Acreditamos que, em um curto espaço de tempo, a concentração desse fungo no solo, resultado das sucessivas aplicações, permitirá o controle da praga somente com essa ação.
Além do controle das cigarrinhas, esse fungo vem mostrando redução dos ovos da broca-da-cana (Diatraea saccharalis) e broca-gigante (Telchin licus) e está colonizando as cochoni-

40
Tecnobio
Shutterstock
Por Thiago de Paula e Silva Gerente Fitotecnia Corporativo na BP Bunge Bioenergia
lhas-das-bainhas, que vêm aumentando gradativamente em algumas variedades em determinado período do ano. O fungo Cordyceps (=Isaria) fumosorosea tem mostrado resultados satisfatórios para o controle das cigarrinhas, além de ter excelente atuação de controle em broca-da-cana.
Para a broca-da-cana, além de todos os benefícios indiretos já citados, fazemos a liberação de Cotesia flavipes via drone em 100% de nossas áreas. A distribuição aérea, que obedece a um planejamento georreferenciado para a melhor eficiência de localiza-
ção, garante resultados adequados para o bom manejo. Um deles é a redução do tempo de distribuição do agente biológico, que pode variar de 15% a 20% em relação ao sistema manual.
A liberação de C. flavipes é feita de forma complementar à aplicação de inseticidas, para que consiga controlar os possíveis escapes que possam vir a ter da aplicação do defensivo, visto que um percentual da infestação presente em campo pode ter uma diferença de momento do ciclo biológico, e, com esse manejo, conseguimos fazer um controle de uma
maneira mais eficiente, garantindo que a área permaneça com uma infestação baixa, dentro dos níveis aceitáveis. Para essa próxima safra, iremos validar a utilização de Tetrastichus howardi como alternativa para a aplicação de C. flavipes

Com relação ao controle de Sphenophorus levis, atualmente utilizamos a Beauveria bassiana em todas as áreas com a presença da praga. Essa aplicação é feita no período de maior ocorrência de adultos, que normalmente fica dentro do período úmido na região Centro Sul. Ainda com atuação biológica nessa praga,

41 Tecnobio
Cigarrinha infectada por Metarhizium
Cochonilha infectada por Metarhizium
nos últimos dois anos estamos utilizando nematoides entomopatogênicos (Heterorhabditis bacteriophora), que neste caso é benéfico e vem trazendo bons resultados com redução de população da praga.
É importante ressaltar, que para a melhor eficiência de controle dessa praga e redução da população logo no início de instalação da cultura, o principal manejo é feito no preparo de solo, através de eliminador de soqueira, para realmente erradicar todas as formas biológicas que estavam presentes na cultura anterior, além dos manejos no sulco de plantio e na soqueira, dentro

de um manejo integrado, para garantir um controle satisfatório.
Outra praga de extrema relevância é Migdolus fryanus, que tem presença regionalizada em algumas de nossas usinas. É uma praga de difícil controle, e, por isso, demanda diferentes estratégias de manejo. Nesses locais, fazemos a coleta massal da praga no período da revoada, que consiste em instalar armadilhas com feromônio ao redor dos talhões que tem a presença da praga, visando retirar os machos da área, reduzindo a cópula e, consequentemente, uma menor quantidade de ovos e larvas em campo.
Para chegarmos nesse modelo atual, foram necessários alguns estudos prévios, como conhecer exatamente o hábito da praga, analisando qual o período para instalação, horário de saída do solo, caminhamento, entre outros, e não só estar ligado ao ciclo biológico. Assim como nas demais pragas, é importante ressaltar que essa é uma parte do manejo como um todo, não podendo deixar de fazer a barreira química no preparo de solo, além de intervenções no sulco de plantio e na soqueira.
Um dos nossos grandes êxitos está no controle da broca-gigante, resul-
42 Tecnobio
Liberação de Cotesia flavipes via drone
tado de um conjunto de práticas, desde o preparo de solo, plantio e tratos culturais. O nosso maior foco hoje é com relação à redução da população de adultos. Atrelado ao processo, notamos que o uso do M. anisopliae, o mesmo fungo para controle da cigarrinha-das-raízes, atua indiretamente pela infecção de ovos de broca-gigante.
Nutrição
Com relação aos demais microrganismos voltados para nutrição, destaque para a fixação biológica de nitrogênio e a solubilização de alguns nutrientes, além da ativação de alguns hormônios. Esses recursos promovem o crescimento das raízes, tornando as plantas mais resistentes e trazendo benefícios como melhor absorção de nutrientes e água, levando para um melhor aumento de produtividade, e reduzindo a dependência de adubações minerais, visto que conseguem otimizar melhor os nutrientes já existentes no solo.
Além de alguns produtos que estamos aplicando para outros fins, como os bioinsumos para controle de nematoides que indiretamente tem atuação em alguns dos fato-



res mencionados anteriormente, no sulco de plantio em 100% de nossas áreas usamos o Nitrospirillum amazonense e, em 100% de nossa área de tratos, fazemos a aplicação do Azospirillum brasilense, ambos voltados para a fixação biológica de nitrogênio, com foco em reduzir as doses de aplicação desse nutriente de forma mineral.


Já estamos com inúmeros trabalhos a campo com outros bioinsumos para capturar o fósforo que temos disponível em nossos solos, fazendo com que possamos diminuir também a adubação mineral deste nutriente, otimizando melhor os recursos que temos em nossos solos.
De forma geral o manejo biológico deixou de ser complementar e se tornou essencial para o manejo da cana-de-açúcar. Temos bioprodutos capazes de substituir o manejo químico com eficiência similar ou até superior, e outros que, em breve, irão dispensar qualquer outro tratamento, pela inoculação e reativação de microrganismos de solo. No processo diário de evolução na gestão do campo, é essencial melhorar a produtividade e a qualidade, promovendo economia de recursos financeiros e ambientais.
43 Tecnobio
Liberação de Cotesia flavipes via drone
Armadilha de feromônio para migdolus Machos de Migdolus fryanus coletados em armadilha de feromônio
Sphenophorus levis parasitado por Heterorhabditis bacteriophora
Ovos de broca-gigante parcialmente parasitados por Metarhizium anisopliae
UMA REVOLUÇÃO NO CONTROLE DAS PRAGAS DOS CANAVIAIS!
A cana-de-açúcar é uma das culturas mais importantes do Brasil e um orgulho para os brasileiros, pela alta tecnologia que desenvolve e usa. Isso é necessário, pois a cultura sofre com as intempéries ambientais, com os solos mais fracos e pobres e com os problemas fitossanitários.
Dentre os problemas fitossanitários estão o ataque de diversas pragas e os surtos de diversas doenças. A broca-da-cana, Diatraea saccharalis e D. impersonatella, é a principal praga da
parta aérea da cultura e os nematoides dos gêneros Pratylenchus e Meloidoyne estão entre as pragas importantes do solo. Ambas as pragas derrubam a produtividade dos canaviais de forma silenciosa, uma “comendo” por cima e as outras por baixo.
A queda na produtividade causada pela broca gira em torno de 1% para cada 0,7% de índice de intensidade de infestação ou quando 5.000 lagartas grandes se alimentam dos colmos por um mês. Para os nematoi-

des são necessários 25-90 juvenis ou adultos de Meloidogyne ou 250-1.000 de Pratylenchus por 50 g de raízes para se perder, mais ou menos, 1% na produtividade em cana-planta - soca (valores estimados).
Não se pode brincar com essas pragas! São muitas as opções para o controle das lagartas de primeiros instares da broca-da-cana, mas são poucas as opções ovicidas. Segundo Paulo S. M. Botelho, os ovos da broca-da-ca-

44 Empresa
Por Dr. Alexandre de Sene Pinto Sócio e Consultor em Manejo Inteligente de Pragas da Occasio, Piracicaba, SP
Shutterstock
B bassiana ESALQ PL63 (500)
Flubendiamida (100)
Clorantraniliproli
I. fumosorosea ESALQ1296 (500)




















Metoxifenozida + espinetoram (200) Testemunha
Diflubenzurom (50)
Metoxifenozida + espinetoram (150)
Triflumurom (80)
l o r a n t r a n ili p r o l e
Período de ação de inseticidas no controle da broca-da-cana. Indiara, GO, pulverização em 05/01/2021.
na são o fator-chave de crescimento populacional dessa espécie, ou seja, se essa fase for afetada a praga tem dificuldade de se restabelecer no canavial durante a safra. É uma opção muito importante.
Recentemente, a Corteva lançou um produto novo no mercado, o Revolux, que tem como princípios ativos metoxifenozida e espinetoram, um inseticida fisiológico e uma espinosina. O Revolux, além da comum ação larvicida dos demais inseticidas, tem ação ovicida, o que amplia a sua eficácia e período de ação em campo.
Nos nossos testes em campo, o Revolux vem se destacando e ganhando espaço entre os chamados “produtos de elite” ou “classe A” para o controle da broca-da-cana, até então dominados pelas diamidas. E surge como uma opção para a rotação de grupos químicos com os demais produtos já utilizados.
No contexto de Manejo Integrado de Pragas, o Revolux é uma ótima opção,

45 Empresa
0,0 0,5 1,0 1,5 2,0 2,5 14 28 I n f es t a ç ã o n o t o p o d o c o l m o ( % )
a aplicação
Dias pós
Be au ve r i a D i fl ub e n z u r o m 49 63 70
T r ifl u m u r o m I s a r i a F l ub e nd i a m i d a R e v o l u x 15 0 R e v o l u x 20 0 Shutterstock
C
pois é muito seletivo para Cotesia flavipes e Trichogramma galloi, ambas liberadas para o controle da broca-da-cana. Também é seletivo para os fungos e bactérias utilizadas nos canaviais para o controle de nematoides, de patógenos fitopatogênicos e de pragas e como bioestimulantes ou disponibilizadores de nutrientes.
E é seletivo para os predadores de ocorrência natural no campo, como os crisopídeos da espécie Chrysoperla externa
Os nematoides fitopatogênicos eram controlados, até 2021, predominantemente por nematicidas químicos, mas em 2022 os bionematicidas superaram eles em área tratada. A Corteva, conectada com as inovações do setor, está lançando um bionematici-
da a base da bactéria Bacillus amyloliquefaciens para a cana-de-açúcar, o Inlayon Eco.



Nos nossos ensaios, o Inlayon Eco tem mostrado bom controle de nematoides e tem contribuído para o aumento de produtividade dos canaviais, em todo o Brasil.
Por enquanto esse produto tem sido usado para o controle de nematoides, mas certamente outras ações secundárias serão exploradas em breve, talvez tão importantes como a função principal.
Particularmente, tenho observado eficácia muito alta no controle de Meloidogyne e alta para Pratylenchus, com reflexos no desenvolvi-
mento das plantas e na produtividade da cultura.
Em minhas consultorias, tenho indicado Bacillus amyloliquefaciens para o controle da maioria dos patógenos que causam doenças nas plantas de soja e de outras culturas. Na cana-de-açúcar, também tem ação contra as doenças de solo, como bioestimulante e disponibilizadora de nutrientes para as plantas. E provavelmente terá ação contra as ferrugens dessa cultura.
O setor canavieiro vem passando por muitas mudanças e o lançamento de novos produtos, químicos de baixo impacto ambiental e biológicos multiusos, é uma enorme contribuição para o agricultor.
46 Empresa
39,3 Testemunha P r o du � v i dad e ( t / ha ) 53,8 55,8
Produtividade média de canaviais tratados com diferentes produtos. Paranacity, PR, plantio em 13/08/ 2021.
Inlayon Eco
Aproach + Inlayon Eco

Revista de Controle Biológico

























































 Por Dra. Tamara Akemi Takahashi
Por Dra. Tamara Akemi Takahashi

 Por Profa. Dra. Darclet Teresinha Malerbo-Souza Setor de Apicultura e Meliponicultura, Departamento de Zootecnia, Universidade Federal Rural de Pernambuco, Recife, PE
Por Profa. Dra. Darclet Teresinha Malerbo-Souza Setor de Apicultura e Meliponicultura, Departamento de Zootecnia, Universidade Federal Rural de Pernambuco, Recife, PE






















































 Morte de perfilho de cana-de-açúcar causada por cupins subterrâneos.
Soldado de Heterotermes tenuis
Ataque de Heterotermes tenuis em rizoma de cana-de-açúcar.
Morte de perfilho de cana-de-açúcar causada por cupins subterrâneos.
Soldado de Heterotermes tenuis
Ataque de Heterotermes tenuis em rizoma de cana-de-açúcar.